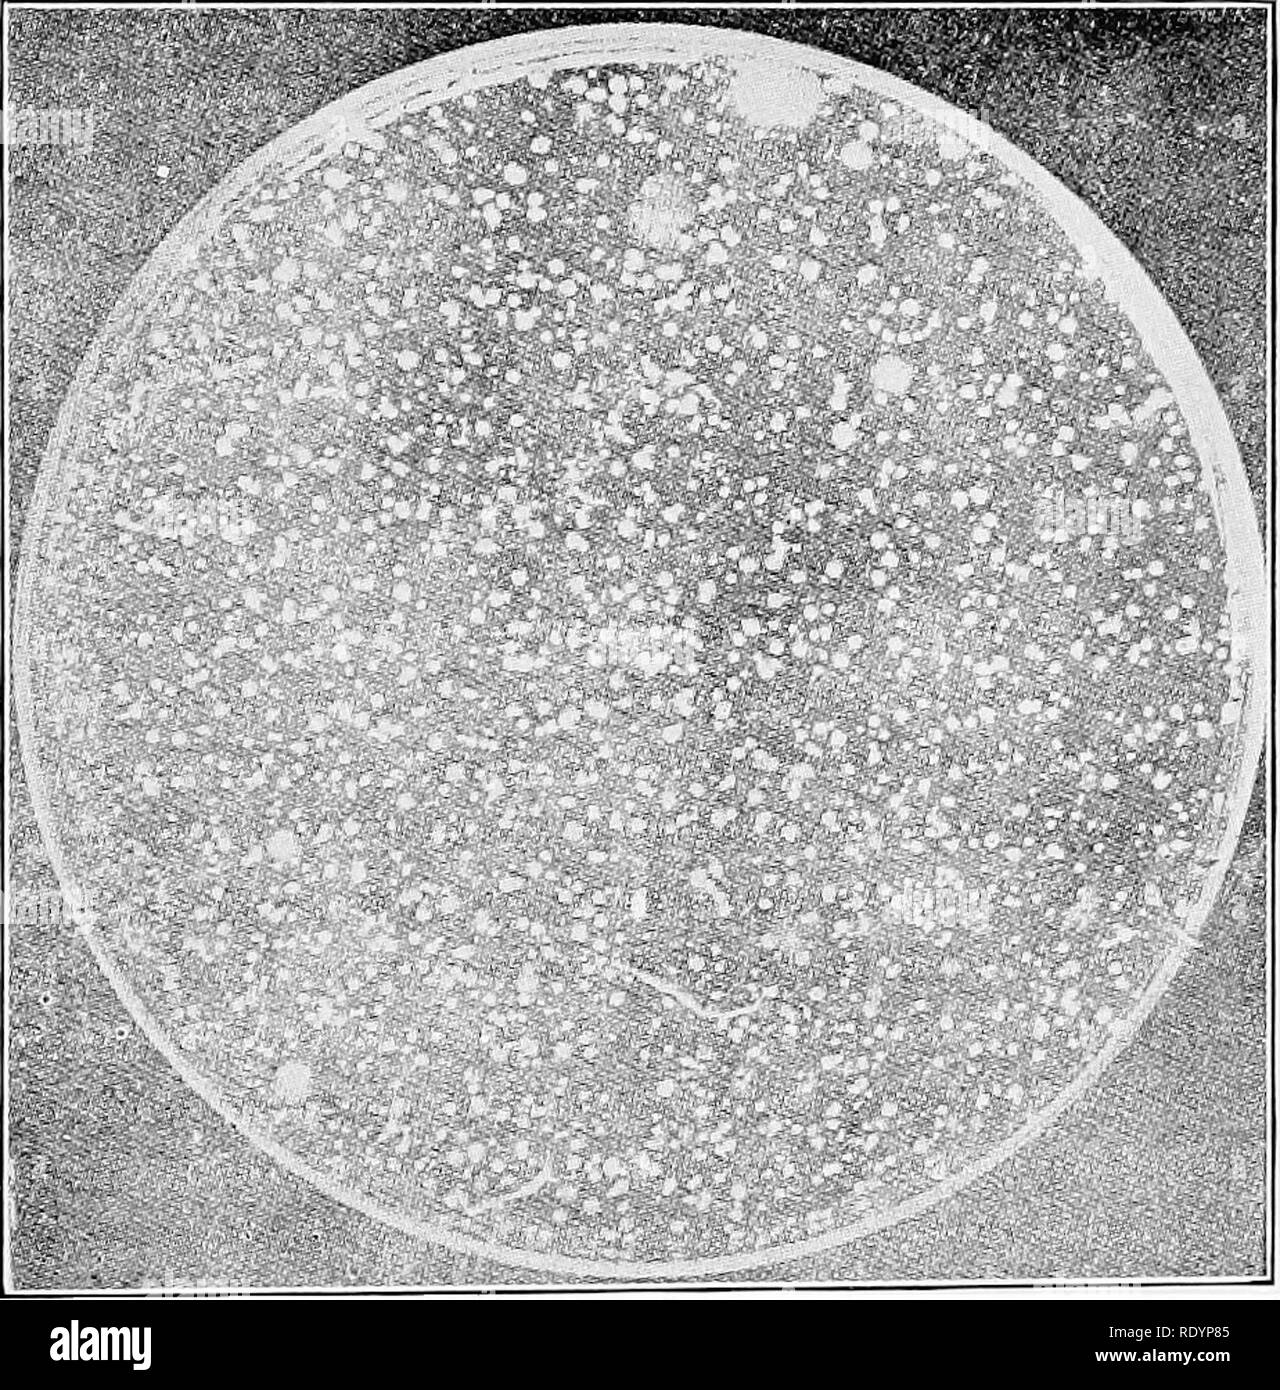
. Prinzipien und Praxis von Butter; eine Abhandlung über die chemischen und physikalischen Eigenschaften von Milch und seine Komponenten, dem Umgang mit Milch und Sahne, und die Herstellung von Butter davon. Butter und Milch. Gärt IN DER MILCH. 51 wird eine Reihe von Arten, die dieser Gruppe angehören. Die patho-transgene Keime, oder Krankheit-produzierende Bakterien, muss auch mit den schädlichen Bakterien eingestuft werden. Es ist nicht die Absicht, die in dieser Arbeit eine längere Debatte über dieses Thema zu geben. Für eine solche Diskussion siehe besondere Werke auf Molkerei Bakteriologie.. Tanne,. 10. âShows Platte ausgesetzt eine halbe Minute unter der kuh euter behandelt Stockfoto

Spezielle diskussion Schwarz-Weiß-Archivfotos
 . Cyclopedia der amerikanischen Gartenbau, bestehend aus Anregungen für den Anbau von Gartenpflanzen, Beschreibungen der Arten von Obst, Gemüse, Blumen und Zierpflanzen in den Vereinigten Staaten und in Kanada verkauft, zusammen mit geographischen und Biographische Skizzen. Im Garten arbeiten. Traube themore leicht gewachsen und kosmopolitischen einheimischer Sorten. Unter Glas, aber die vinit'era Sorten gedeihen; unten eine spezielle Diskussion ist zu diesem Zweig des Themas gegeben. Die größte Entwicklung von Tlic native ("Irape indus - versuchen Sie in New York und LUiin getroffen hat, angrenzenden Seen und großen s Stockfotohttps://www.alamy.de/image-license-details/?v=1https://www.alamy.de/cyclopedia-der-amerikanischen-gartenbau-bestehend-aus-anregungen-fur-den-anbau-von-gartenpflanzen-beschreibungen-der-arten-von-obst-gemuse-blumen-und-zierpflanzen-in-den-vereinigten-staaten-und-in-kanada-verkauft-zusammen-mit-geographischen-und-biographische-skizzen-im-garten-arbeiten-traube-themore-leicht-gewachsen-und-kosmopolitischen-einheimischer-sorten-unter-glas-aber-die-vinitera-sorten-gedeihen-unten-eine-spezielle-diskussion-ist-zu-diesem-zweig-des-themas-gegeben-die-grosste-entwicklung-von-tlic-native-irape-indus-versuchen-sie-in-new-york-und-luiin-getroffen-hat-angrenzenden-seen-und-grossen-s-image232393868.html
. Cyclopedia der amerikanischen Gartenbau, bestehend aus Anregungen für den Anbau von Gartenpflanzen, Beschreibungen der Arten von Obst, Gemüse, Blumen und Zierpflanzen in den Vereinigten Staaten und in Kanada verkauft, zusammen mit geographischen und Biographische Skizzen. Im Garten arbeiten. Traube themore leicht gewachsen und kosmopolitischen einheimischer Sorten. Unter Glas, aber die vinit'era Sorten gedeihen; unten eine spezielle Diskussion ist zu diesem Zweig des Themas gegeben. Die größte Entwicklung von Tlic native ("Irape indus - versuchen Sie in New York und LUiin getroffen hat, angrenzenden Seen und großen s Stockfotohttps://www.alamy.de/image-license-details/?v=1https://www.alamy.de/cyclopedia-der-amerikanischen-gartenbau-bestehend-aus-anregungen-fur-den-anbau-von-gartenpflanzen-beschreibungen-der-arten-von-obst-gemuse-blumen-und-zierpflanzen-in-den-vereinigten-staaten-und-in-kanada-verkauft-zusammen-mit-geographischen-und-biographische-skizzen-im-garten-arbeiten-traube-themore-leicht-gewachsen-und-kosmopolitischen-einheimischer-sorten-unter-glas-aber-die-vinitera-sorten-gedeihen-unten-eine-spezielle-diskussion-ist-zu-diesem-zweig-des-themas-gegeben-die-grosste-entwicklung-von-tlic-native-irape-indus-versuchen-sie-in-new-york-und-luiin-getroffen-hat-angrenzenden-seen-und-grossen-s-image232393868.htmlRMRE2CN0–. Cyclopedia der amerikanischen Gartenbau, bestehend aus Anregungen für den Anbau von Gartenpflanzen, Beschreibungen der Arten von Obst, Gemüse, Blumen und Zierpflanzen in den Vereinigten Staaten und in Kanada verkauft, zusammen mit geographischen und Biographische Skizzen. Im Garten arbeiten. Traube themore leicht gewachsen und kosmopolitischen einheimischer Sorten. Unter Glas, aber die vinit'era Sorten gedeihen; unten eine spezielle Diskussion ist zu diesem Zweig des Themas gegeben. Die größte Entwicklung von Tlic native ("Irape indus - versuchen Sie in New York und LUiin getroffen hat, angrenzenden Seen und großen s
 . Imkerei, eine Diskussion über das Leben der Honigbiene und der Produktion von Honig. Bienen und Honig. Das Leben des Einzelnen 95 ten Teil des protoplasma ist vor allem während der Zellteilung aktiv und trägt der besonderen Organe (Chromosomen), instrumental als Träger der erblichen Zeichen. Den Kern und die umgebende Protoplasma sind eng in ihren Funktionen vereint und sind nicht in der Lage, SEPA-rate Existenz. Der Kern ist in seiner ruhenden Zustand, in der Regel in Form abgerundet, während die restlichen Protoplasma ist in verschiedenen Formen nach der speziellen Funktionen des c Stockfotohttps://www.alamy.de/image-license-details/?v=1https://www.alamy.de/imkerei-eine-diskussion-uber-das-leben-der-honigbiene-und-der-produktion-von-honig-bienen-und-honig-das-leben-des-einzelnen-95-ten-teil-des-protoplasma-ist-vor-allem-wahrend-der-zellteilung-aktiv-und-tragt-der-besonderen-organe-chromosomen-instrumental-als-trager-der-erblichen-zeichen-den-kern-und-die-umgebende-protoplasma-sind-eng-in-ihren-funktionen-vereint-und-sind-nicht-in-der-lage-sepa-rate-existenz-der-kern-ist-in-seiner-ruhenden-zustand-in-der-regel-in-form-abgerundet-wahrend-die-restlichen-protoplasma-ist-in-verschiedenen-formen-nach-der-speziellen-funktionen-des-c-image232062083.html
. Imkerei, eine Diskussion über das Leben der Honigbiene und der Produktion von Honig. Bienen und Honig. Das Leben des Einzelnen 95 ten Teil des protoplasma ist vor allem während der Zellteilung aktiv und trägt der besonderen Organe (Chromosomen), instrumental als Träger der erblichen Zeichen. Den Kern und die umgebende Protoplasma sind eng in ihren Funktionen vereint und sind nicht in der Lage, SEPA-rate Existenz. Der Kern ist in seiner ruhenden Zustand, in der Regel in Form abgerundet, während die restlichen Protoplasma ist in verschiedenen Formen nach der speziellen Funktionen des c Stockfotohttps://www.alamy.de/image-license-details/?v=1https://www.alamy.de/imkerei-eine-diskussion-uber-das-leben-der-honigbiene-und-der-produktion-von-honig-bienen-und-honig-das-leben-des-einzelnen-95-ten-teil-des-protoplasma-ist-vor-allem-wahrend-der-zellteilung-aktiv-und-tragt-der-besonderen-organe-chromosomen-instrumental-als-trager-der-erblichen-zeichen-den-kern-und-die-umgebende-protoplasma-sind-eng-in-ihren-funktionen-vereint-und-sind-nicht-in-der-lage-sepa-rate-existenz-der-kern-ist-in-seiner-ruhenden-zustand-in-der-regel-in-form-abgerundet-wahrend-die-restlichen-protoplasma-ist-in-verschiedenen-formen-nach-der-speziellen-funktionen-des-c-image232062083.htmlRMRDF9FF–. Imkerei, eine Diskussion über das Leben der Honigbiene und der Produktion von Honig. Bienen und Honig. Das Leben des Einzelnen 95 ten Teil des protoplasma ist vor allem während der Zellteilung aktiv und trägt der besonderen Organe (Chromosomen), instrumental als Träger der erblichen Zeichen. Den Kern und die umgebende Protoplasma sind eng in ihren Funktionen vereint und sind nicht in der Lage, SEPA-rate Existenz. Der Kern ist in seiner ruhenden Zustand, in der Regel in Form abgerundet, während die restlichen Protoplasma ist in verschiedenen Formen nach der speziellen Funktionen des c
 . Die Enzyklopädie der praktischen Gartenbau; eine Referenz System der kommerziellen Gartenbau, über die praktische und wissenschaftliche Phasen der Gartenbau, mit besonderem Bezug auf Obst und Gemüse;. Gartenarbeit; Obst - Kultur; Gemüseanbau. 1622 ENZYKLOPÄDIE DER PRAKTISCHEN GARTENBAU Tlie Keim der Erreger dieser Krankheit verursacht benannt wird durch Bakteriologen" "Bacillus amylovorus." "Für unsere Zwecke der Diskussion, die wir es der pear-oiight Bazillus nennen könnten, die PEAR-blight Keim oder der pear-blight Mikrobe, all diese Begriffe bedeuten praktisch die gleiche Sache. Diese Keime sind unter den mi Stockfotohttps://www.alamy.de/image-license-details/?v=1https://www.alamy.de/die-enzyklopadie-der-praktischen-gartenbau-eine-referenz-system-der-kommerziellen-gartenbau-uber-die-praktische-und-wissenschaftliche-phasen-der-gartenbau-mit-besonderem-bezug-auf-obst-und-gemuse-gartenarbeit-obst-kultur-gemuseanbau-1622-enzyklopadie-der-praktischen-gartenbau-tlie-keim-der-erreger-dieser-krankheit-verursacht-benannt-wird-durch-bakteriologen-bacillus-amylovorus-fur-unsere-zwecke-der-diskussion-die-wir-es-der-pear-oiight-bazillus-nennen-konnten-die-pear-blight-keim-oder-der-pear-blight-mikrobe-all-diese-begriffe-bedeuten-praktisch-die-gleiche-sache-diese-keime-sind-unter-den-mi-image231897823.html
. Die Enzyklopädie der praktischen Gartenbau; eine Referenz System der kommerziellen Gartenbau, über die praktische und wissenschaftliche Phasen der Gartenbau, mit besonderem Bezug auf Obst und Gemüse;. Gartenarbeit; Obst - Kultur; Gemüseanbau. 1622 ENZYKLOPÄDIE DER PRAKTISCHEN GARTENBAU Tlie Keim der Erreger dieser Krankheit verursacht benannt wird durch Bakteriologen" "Bacillus amylovorus." "Für unsere Zwecke der Diskussion, die wir es der pear-oiight Bazillus nennen könnten, die PEAR-blight Keim oder der pear-blight Mikrobe, all diese Begriffe bedeuten praktisch die gleiche Sache. Diese Keime sind unter den mi Stockfotohttps://www.alamy.de/image-license-details/?v=1https://www.alamy.de/die-enzyklopadie-der-praktischen-gartenbau-eine-referenz-system-der-kommerziellen-gartenbau-uber-die-praktische-und-wissenschaftliche-phasen-der-gartenbau-mit-besonderem-bezug-auf-obst-und-gemuse-gartenarbeit-obst-kultur-gemuseanbau-1622-enzyklopadie-der-praktischen-gartenbau-tlie-keim-der-erreger-dieser-krankheit-verursacht-benannt-wird-durch-bakteriologen-bacillus-amylovorus-fur-unsere-zwecke-der-diskussion-die-wir-es-der-pear-oiight-bazillus-nennen-konnten-die-pear-blight-keim-oder-der-pear-blight-mikrobe-all-diese-begriffe-bedeuten-praktisch-die-gleiche-sache-diese-keime-sind-unter-den-mi-image231897823.htmlRMRD7T13–. Die Enzyklopädie der praktischen Gartenbau; eine Referenz System der kommerziellen Gartenbau, über die praktische und wissenschaftliche Phasen der Gartenbau, mit besonderem Bezug auf Obst und Gemüse;. Gartenarbeit; Obst - Kultur; Gemüseanbau. 1622 ENZYKLOPÄDIE DER PRAKTISCHEN GARTENBAU Tlie Keim der Erreger dieser Krankheit verursacht benannt wird durch Bakteriologen" "Bacillus amylovorus." "Für unsere Zwecke der Diskussion, die wir es der pear-oiight Bazillus nennen könnten, die PEAR-blight Keim oder der pear-blight Mikrobe, all diese Begriffe bedeuten praktisch die gleiche Sache. Diese Keime sind unter den mi
 . Imkerei, eine Diskussion über das Leben der Honigbiene und der Produktion von Honig. Bienen und Honig. 112 Imkerei Schiemenz/und nach ihm von Cheshire,^ die Quelle der Nahrung durch die Arbeit gegeben werden - ers zu den larvse der Königinnen, Drohnen und Arbeiterinnen. Es wird behauptet, dass die Entwicklung dieser Drüsen in Anteil auf die besondere Ghettoisierung der Arten, die in der Ernährung der larvffi; in Hummeln (BOMBUS) Sie sind sowie der Biene entwickelt. Sie sind weniger anstrengend für die zunehmend in Psi kleinere thyrus, Andrena und Anthophora. Da die Verfütterung von einigen dieser Arten ist völlig anders als die Stockfotohttps://www.alamy.de/image-license-details/?v=1https://www.alamy.de/imkerei-eine-diskussion-uber-das-leben-der-honigbiene-und-der-produktion-von-honig-bienen-und-honig-112-imkerei-schiemenzund-nach-ihm-von-cheshire-die-quelle-der-nahrung-durch-die-arbeit-gegeben-werden-ers-zu-den-larvse-der-koniginnen-drohnen-und-arbeiterinnen-es-wird-behauptet-dass-die-entwicklung-dieser-drusen-in-anteil-auf-die-besondere-ghettoisierung-der-arten-die-in-der-ernahrung-der-larvffi-in-hummeln-bombus-sie-sind-sowie-der-biene-entwickelt-sie-sind-weniger-anstrengend-fur-die-zunehmend-in-psi-kleinere-thyrus-andrena-und-anthophora-da-die-verfutterung-von-einigen-dieser-arten-ist-vollig-anders-als-die-image232061972.html
. Imkerei, eine Diskussion über das Leben der Honigbiene und der Produktion von Honig. Bienen und Honig. 112 Imkerei Schiemenz/und nach ihm von Cheshire,^ die Quelle der Nahrung durch die Arbeit gegeben werden - ers zu den larvse der Königinnen, Drohnen und Arbeiterinnen. Es wird behauptet, dass die Entwicklung dieser Drüsen in Anteil auf die besondere Ghettoisierung der Arten, die in der Ernährung der larvffi; in Hummeln (BOMBUS) Sie sind sowie der Biene entwickelt. Sie sind weniger anstrengend für die zunehmend in Psi kleinere thyrus, Andrena und Anthophora. Da die Verfütterung von einigen dieser Arten ist völlig anders als die Stockfotohttps://www.alamy.de/image-license-details/?v=1https://www.alamy.de/imkerei-eine-diskussion-uber-das-leben-der-honigbiene-und-der-produktion-von-honig-bienen-und-honig-112-imkerei-schiemenzund-nach-ihm-von-cheshire-die-quelle-der-nahrung-durch-die-arbeit-gegeben-werden-ers-zu-den-larvse-der-koniginnen-drohnen-und-arbeiterinnen-es-wird-behauptet-dass-die-entwicklung-dieser-drusen-in-anteil-auf-die-besondere-ghettoisierung-der-arten-die-in-der-ernahrung-der-larvffi-in-hummeln-bombus-sie-sind-sowie-der-biene-entwickelt-sie-sind-weniger-anstrengend-fur-die-zunehmend-in-psi-kleinere-thyrus-andrena-und-anthophora-da-die-verfutterung-von-einigen-dieser-arten-ist-vollig-anders-als-die-image232061972.htmlRMRDF9BG–. Imkerei, eine Diskussion über das Leben der Honigbiene und der Produktion von Honig. Bienen und Honig. 112 Imkerei Schiemenz/und nach ihm von Cheshire,^ die Quelle der Nahrung durch die Arbeit gegeben werden - ers zu den larvse der Königinnen, Drohnen und Arbeiterinnen. Es wird behauptet, dass die Entwicklung dieser Drüsen in Anteil auf die besondere Ghettoisierung der Arten, die in der Ernährung der larvffi; in Hummeln (BOMBUS) Sie sind sowie der Biene entwickelt. Sie sind weniger anstrengend für die zunehmend in Psi kleinere thyrus, Andrena und Anthophora. Da die Verfütterung von einigen dieser Arten ist völlig anders als die
 . Lehrbuch der Gartenkunst, vor allem für die Verwendung von nicht-professionellen Studenten. Gartenbau. Lektion 34 Gehöft Gruppe seine Lektion erhalten Sie die Gelegenheit, die wirtschaftlichen und künstlerischen Gruppierung von landwirtschaftlichen Gebäuden zu studieren. Die Überlegungen, die hier einen besonderen Verweis auf Bedingungen, die in der Prärie Landwirtschaft Staaten des Mittleren Westens präsentiert, obwohl weitgehend die gleichen Prinzipien, die das Layout einer Farm Group überall bestimmen sollten. Definition Für den Zweck dieser Diskussion einen Bauernhof verstanden ist eine Gruppe von Gebäuden auf einem Bauernhof verwendet werden, mit den angrenzenden Stockfotohttps://www.alamy.de/image-license-details/?v=1https://www.alamy.de/lehrbuch-der-gartenkunst-vor-allem-fur-die-verwendung-von-nicht-professionellen-studenten-gartenbau-lektion-34-gehoft-gruppe-seine-lektion-erhalten-sie-die-gelegenheit-die-wirtschaftlichen-und-kunstlerischen-gruppierung-von-landwirtschaftlichen-gebauden-zu-studieren-die-uberlegungen-die-hier-einen-besonderen-verweis-auf-bedingungen-die-in-der-prarie-landwirtschaft-staaten-des-mittleren-westens-prasentiert-obwohl-weitgehend-die-gleichen-prinzipien-die-das-layout-einer-farm-group-uberall-bestimmen-sollten-definition-fur-den-zweck-dieser-diskussion-einen-bauernhof-verstanden-ist-eine-gruppe-von-gebauden-auf-einem-bauernhof-verwendet-werden-mit-den-angrenzenden-image232180292.html
. Lehrbuch der Gartenkunst, vor allem für die Verwendung von nicht-professionellen Studenten. Gartenbau. Lektion 34 Gehöft Gruppe seine Lektion erhalten Sie die Gelegenheit, die wirtschaftlichen und künstlerischen Gruppierung von landwirtschaftlichen Gebäuden zu studieren. Die Überlegungen, die hier einen besonderen Verweis auf Bedingungen, die in der Prärie Landwirtschaft Staaten des Mittleren Westens präsentiert, obwohl weitgehend die gleichen Prinzipien, die das Layout einer Farm Group überall bestimmen sollten. Definition Für den Zweck dieser Diskussion einen Bauernhof verstanden ist eine Gruppe von Gebäuden auf einem Bauernhof verwendet werden, mit den angrenzenden Stockfotohttps://www.alamy.de/image-license-details/?v=1https://www.alamy.de/lehrbuch-der-gartenkunst-vor-allem-fur-die-verwendung-von-nicht-professionellen-studenten-gartenbau-lektion-34-gehoft-gruppe-seine-lektion-erhalten-sie-die-gelegenheit-die-wirtschaftlichen-und-kunstlerischen-gruppierung-von-landwirtschaftlichen-gebauden-zu-studieren-die-uberlegungen-die-hier-einen-besonderen-verweis-auf-bedingungen-die-in-der-prarie-landwirtschaft-staaten-des-mittleren-westens-prasentiert-obwohl-weitgehend-die-gleichen-prinzipien-die-das-layout-einer-farm-group-uberall-bestimmen-sollten-definition-fur-den-zweck-dieser-diskussion-einen-bauernhof-verstanden-ist-eine-gruppe-von-gebauden-auf-einem-bauernhof-verwendet-werden-mit-den-angrenzenden-image232180292.htmlRMRDMM98–. Lehrbuch der Gartenkunst, vor allem für die Verwendung von nicht-professionellen Studenten. Gartenbau. Lektion 34 Gehöft Gruppe seine Lektion erhalten Sie die Gelegenheit, die wirtschaftlichen und künstlerischen Gruppierung von landwirtschaftlichen Gebäuden zu studieren. Die Überlegungen, die hier einen besonderen Verweis auf Bedingungen, die in der Prärie Landwirtschaft Staaten des Mittleren Westens präsentiert, obwohl weitgehend die gleichen Prinzipien, die das Layout einer Farm Group überall bestimmen sollten. Definition Für den Zweck dieser Diskussion einen Bauernhof verstanden ist eine Gruppe von Gebäuden auf einem Bauernhof verwendet werden, mit den angrenzenden
 . Imkerei, eine Diskussion über das Leben der Honigbiene und der Produktion von Honig. Bienen und Honig. 62 Imkerei möglicherweise zu den einfachen Kernspaltung oder Abteilung in der Protozoen, durch die sie in die Zahl vergrößern beobachtet verglichen werden. Vorbereitung für das Schwärmen. Als die Kolonie steigt in der Stärke, die Aufzucht der Brut nicht mehr an den Arbeitnehmer und drone Zellen aber spezielle Königin Zellen beschränkt werden gebaut (Abb. 45), in der die Weiblichen Larven sind ein speziell zubereitetes Essen, Gelee Royale gefüttert, und in denen, die im Laufe der Entwicklung derart geändert, dass es Ergebnis Königinnen mit ihren besonderen Organe statt o Stockfotohttps://www.alamy.de/image-license-details/?v=1https://www.alamy.de/imkerei-eine-diskussion-uber-das-leben-der-honigbiene-und-der-produktion-von-honig-bienen-und-honig-62-imkerei-moglicherweise-zu-den-einfachen-kernspaltung-oder-abteilung-in-der-protozoen-durch-die-sie-in-die-zahl-vergrossern-beobachtet-verglichen-werden-vorbereitung-fur-das-schwarmen-als-die-kolonie-steigt-in-der-starke-die-aufzucht-der-brut-nicht-mehr-an-den-arbeitnehmer-und-drone-zellen-aber-spezielle-konigin-zellen-beschrankt-werden-gebaut-abb-45-in-der-die-weiblichen-larven-sind-ein-speziell-zubereitetes-essen-gelee-royale-gefuttert-und-in-denen-die-im-laufe-der-entwicklung-derart-geandert-dass-es-ergebnis-koniginnen-mit-ihren-besonderen-organe-statt-o-image232062128.html
. Imkerei, eine Diskussion über das Leben der Honigbiene und der Produktion von Honig. Bienen und Honig. 62 Imkerei möglicherweise zu den einfachen Kernspaltung oder Abteilung in der Protozoen, durch die sie in die Zahl vergrößern beobachtet verglichen werden. Vorbereitung für das Schwärmen. Als die Kolonie steigt in der Stärke, die Aufzucht der Brut nicht mehr an den Arbeitnehmer und drone Zellen aber spezielle Königin Zellen beschränkt werden gebaut (Abb. 45), in der die Weiblichen Larven sind ein speziell zubereitetes Essen, Gelee Royale gefüttert, und in denen, die im Laufe der Entwicklung derart geändert, dass es Ergebnis Königinnen mit ihren besonderen Organe statt o Stockfotohttps://www.alamy.de/image-license-details/?v=1https://www.alamy.de/imkerei-eine-diskussion-uber-das-leben-der-honigbiene-und-der-produktion-von-honig-bienen-und-honig-62-imkerei-moglicherweise-zu-den-einfachen-kernspaltung-oder-abteilung-in-der-protozoen-durch-die-sie-in-die-zahl-vergrossern-beobachtet-verglichen-werden-vorbereitung-fur-das-schwarmen-als-die-kolonie-steigt-in-der-starke-die-aufzucht-der-brut-nicht-mehr-an-den-arbeitnehmer-und-drone-zellen-aber-spezielle-konigin-zellen-beschrankt-werden-gebaut-abb-45-in-der-die-weiblichen-larven-sind-ein-speziell-zubereitetes-essen-gelee-royale-gefuttert-und-in-denen-die-im-laufe-der-entwicklung-derart-geandert-dass-es-ergebnis-koniginnen-mit-ihren-besonderen-organe-statt-o-image232062128.htmlRMRDF9H4–. Imkerei, eine Diskussion über das Leben der Honigbiene und der Produktion von Honig. Bienen und Honig. 62 Imkerei möglicherweise zu den einfachen Kernspaltung oder Abteilung in der Protozoen, durch die sie in die Zahl vergrößern beobachtet verglichen werden. Vorbereitung für das Schwärmen. Als die Kolonie steigt in der Stärke, die Aufzucht der Brut nicht mehr an den Arbeitnehmer und drone Zellen aber spezielle Königin Zellen beschränkt werden gebaut (Abb. 45), in der die Weiblichen Larven sind ein speziell zubereitetes Essen, Gelee Royale gefüttert, und in denen, die im Laufe der Entwicklung derart geändert, dass es Ergebnis Königinnen mit ihren besonderen Organe statt o
 . Prinzipien und Praxis von Geflügel Kultur. Geflügel. Wirtschaftliche ASPEKTE VON GEFLÜGEL KULTUR 33 nach Hause will erfüllt sind. Normalen landwirtschaftlichen Bedingungen und Methoden benötigen, die hier nicht beschrieben werden, aber einige der speziellen Entwicklungen entlang dieser Linie muss als zu Ihren allgemeinen Merkmale beschrieben werden, obwohl diese Funktionen werden Mehr- priately unter spezielle Themen kommen. Factory Methoden in Geflügel Kultur. Die intensive Geflügelhaltung Werk gewidmet vor allem Eierproduktion, mit dem Verkauf von Geflügel und oft reinrassiger Bestand und Bruteier als Zubehör, lange der Mo war Stockfotohttps://www.alamy.de/image-license-details/?v=1https://www.alamy.de/prinzipien-und-praxis-von-geflugel-kultur-geflugel-wirtschaftliche-aspekte-von-geflugel-kultur-33-nach-hause-will-erfullt-sind-normalen-landwirtschaftlichen-bedingungen-und-methoden-benotigen-die-hier-nicht-beschrieben-werden-aber-einige-der-speziellen-entwicklungen-entlang-dieser-linie-muss-als-zu-ihren-allgemeinen-merkmale-beschrieben-werden-obwohl-diese-funktionen-werden-mehr-priately-unter-spezielle-themen-kommen-factory-methoden-in-geflugel-kultur-die-intensive-geflugelhaltung-werk-gewidmet-vor-allem-eierproduktion-mit-dem-verkauf-von-geflugel-und-oft-reinrassiger-bestand-und-bruteier-als-zubehor-lange-der-mo-war-image232951794.html
. Prinzipien und Praxis von Geflügel Kultur. Geflügel. Wirtschaftliche ASPEKTE VON GEFLÜGEL KULTUR 33 nach Hause will erfüllt sind. Normalen landwirtschaftlichen Bedingungen und Methoden benötigen, die hier nicht beschrieben werden, aber einige der speziellen Entwicklungen entlang dieser Linie muss als zu Ihren allgemeinen Merkmale beschrieben werden, obwohl diese Funktionen werden Mehr- priately unter spezielle Themen kommen. Factory Methoden in Geflügel Kultur. Die intensive Geflügelhaltung Werk gewidmet vor allem Eierproduktion, mit dem Verkauf von Geflügel und oft reinrassiger Bestand und Bruteier als Zubehör, lange der Mo war Stockfotohttps://www.alamy.de/image-license-details/?v=1https://www.alamy.de/prinzipien-und-praxis-von-geflugel-kultur-geflugel-wirtschaftliche-aspekte-von-geflugel-kultur-33-nach-hause-will-erfullt-sind-normalen-landwirtschaftlichen-bedingungen-und-methoden-benotigen-die-hier-nicht-beschrieben-werden-aber-einige-der-speziellen-entwicklungen-entlang-dieser-linie-muss-als-zu-ihren-allgemeinen-merkmale-beschrieben-werden-obwohl-diese-funktionen-werden-mehr-priately-unter-spezielle-themen-kommen-factory-methoden-in-geflugel-kultur-die-intensive-geflugelhaltung-werk-gewidmet-vor-allem-eierproduktion-mit-dem-verkauf-von-geflugel-und-oft-reinrassiger-bestand-und-bruteier-als-zubehor-lange-der-mo-war-image232951794.htmlRMREYTAX–. Prinzipien und Praxis von Geflügel Kultur. Geflügel. Wirtschaftliche ASPEKTE VON GEFLÜGEL KULTUR 33 nach Hause will erfüllt sind. Normalen landwirtschaftlichen Bedingungen und Methoden benötigen, die hier nicht beschrieben werden, aber einige der speziellen Entwicklungen entlang dieser Linie muss als zu Ihren allgemeinen Merkmale beschrieben werden, obwohl diese Funktionen werden Mehr- priately unter spezielle Themen kommen. Factory Methoden in Geflügel Kultur. Die intensive Geflügelhaltung Werk gewidmet vor allem Eierproduktion, mit dem Verkauf von Geflügel und oft reinrassiger Bestand und Bruteier als Zubehör, lange der Mo war
 . Grundlagen der Botanik. Botanik; Botanik. 298. Diskussion. - Fueus ist ein viel mehr hoch entwickelte Anlage als die Blau-grün oder grün Algen in den vorherigen Abschnitten untersucht. Sie verfügt über eine komplette zelluläre Struktur und es gibt erhebliche Arbeitsteilung zwischen den verschiedenen Teilen der Anlage. Es hat einen besonderen Holdfast, Blasen zu dienen als Schwimmer, ^eine haltbare Mittelrippe Run- ning längs der Zweige und sie zu stärken, und erweiterte Ränder der Zweige, Leisten - ing ausreichend Fläche für die photosyn-vollpanzerung arbeiten. Die äusseren Schichten der Zellen sind vor allem für die Photosynthese gewidmet Stockfotohttps://www.alamy.de/image-license-details/?v=1https://www.alamy.de/grundlagen-der-botanik-botanik-botanik-298-diskussion-fueus-ist-ein-viel-mehr-hoch-entwickelte-anlage-als-die-blau-grun-oder-grun-algen-in-den-vorherigen-abschnitten-untersucht-sie-verfugt-uber-eine-komplette-zellulare-struktur-und-es-gibt-erhebliche-arbeitsteilung-zwischen-den-verschiedenen-teilen-der-anlage-es-hat-einen-besonderen-holdfast-blasen-zu-dienen-als-schwimmer-eine-haltbare-mittelrippe-run-ning-langs-der-zweige-und-sie-zu-starken-und-erweiterte-rander-der-zweige-leisten-ing-ausreichend-flache-fur-die-photosyn-vollpanzerung-arbeiten-die-ausseren-schichten-der-zellen-sind-vor-allem-fur-die-photosynthese-gewidmet-image232080702.html
. Grundlagen der Botanik. Botanik; Botanik. 298. Diskussion. - Fueus ist ein viel mehr hoch entwickelte Anlage als die Blau-grün oder grün Algen in den vorherigen Abschnitten untersucht. Sie verfügt über eine komplette zelluläre Struktur und es gibt erhebliche Arbeitsteilung zwischen den verschiedenen Teilen der Anlage. Es hat einen besonderen Holdfast, Blasen zu dienen als Schwimmer, ^eine haltbare Mittelrippe Run- ning längs der Zweige und sie zu stärken, und erweiterte Ränder der Zweige, Leisten - ing ausreichend Fläche für die photosyn-vollpanzerung arbeiten. Die äusseren Schichten der Zellen sind vor allem für die Photosynthese gewidmet Stockfotohttps://www.alamy.de/image-license-details/?v=1https://www.alamy.de/grundlagen-der-botanik-botanik-botanik-298-diskussion-fueus-ist-ein-viel-mehr-hoch-entwickelte-anlage-als-die-blau-grun-oder-grun-algen-in-den-vorherigen-abschnitten-untersucht-sie-verfugt-uber-eine-komplette-zellulare-struktur-und-es-gibt-erhebliche-arbeitsteilung-zwischen-den-verschiedenen-teilen-der-anlage-es-hat-einen-besonderen-holdfast-blasen-zu-dienen-als-schwimmer-eine-haltbare-mittelrippe-run-ning-langs-der-zweige-und-sie-zu-starken-und-erweiterte-rander-der-zweige-leisten-ing-ausreichend-flache-fur-die-photosyn-vollpanzerung-arbeiten-die-ausseren-schichten-der-zellen-sind-vor-allem-fur-die-photosynthese-gewidmet-image232080702.htmlRMRDG58E–. Grundlagen der Botanik. Botanik; Botanik. 298. Diskussion. - Fueus ist ein viel mehr hoch entwickelte Anlage als die Blau-grün oder grün Algen in den vorherigen Abschnitten untersucht. Sie verfügt über eine komplette zelluläre Struktur und es gibt erhebliche Arbeitsteilung zwischen den verschiedenen Teilen der Anlage. Es hat einen besonderen Holdfast, Blasen zu dienen als Schwimmer, ^eine haltbare Mittelrippe Run- ning längs der Zweige und sie zu stärken, und erweiterte Ränder der Zweige, Leisten - ing ausreichend Fläche für die photosyn-vollpanzerung arbeiten. Die äusseren Schichten der Zellen sind vor allem für die Photosynthese gewidmet
. Prinzipien und Praxis von Butter; eine Abhandlung über die chemischen und physikalischen Eigenschaften von Milch und seine Komponenten, dem Umgang mit Milch und Sahne, und die Herstellung von Butter davon. Butter und Milch. Gärt IN DER MILCH. 51 wird eine Reihe von Arten, die dieser Gruppe angehören. Die patho-transgene Keime, oder Krankheit-produzierende Bakterien, muss auch mit den schädlichen Bakterien eingestuft werden. Es ist nicht die Absicht, die in dieser Arbeit eine längere Debatte über dieses Thema zu geben. Für eine solche Diskussion siehe besondere Werke auf Molkerei Bakteriologie.. Tanne,. 10. âShows Platte ausgesetzt eine halbe Minute unter der kuh euter behandelt Stockfotohttps://www.alamy.de/image-license-details/?v=1https://www.alamy.de/prinzipien-und-praxis-von-butter-eine-abhandlung-uber-die-chemischen-und-physikalischen-eigenschaften-von-milch-und-seine-komponenten-dem-umgang-mit-milch-und-sahne-und-die-herstellung-von-butter-davon-butter-und-milch-gart-in-der-milch-51-wird-eine-reihe-von-arten-die-dieser-gruppe-angehoren-die-patho-transgene-keime-oder-krankheit-produzierende-bakterien-muss-auch-mit-den-schadlichen-bakterien-eingestuft-werden-es-ist-nicht-die-absicht-die-in-dieser-arbeit-eine-langere-debatte-uber-dieses-thema-zu-geben-fur-eine-solche-diskussion-siehe-besondere-werke-auf-molkerei-bakteriologie-tanne-10-shows-platte-ausgesetzt-eine-halbe-minute-unter-der-kuh-euter-behandelt-image232335493.html
. Prinzipien und Praxis von Butter; eine Abhandlung über die chemischen und physikalischen Eigenschaften von Milch und seine Komponenten, dem Umgang mit Milch und Sahne, und die Herstellung von Butter davon. Butter und Milch. Gärt IN DER MILCH. 51 wird eine Reihe von Arten, die dieser Gruppe angehören. Die patho-transgene Keime, oder Krankheit-produzierende Bakterien, muss auch mit den schädlichen Bakterien eingestuft werden. Es ist nicht die Absicht, die in dieser Arbeit eine längere Debatte über dieses Thema zu geben. Für eine solche Diskussion siehe besondere Werke auf Molkerei Bakteriologie.. Tanne,. 10. âShows Platte ausgesetzt eine halbe Minute unter der kuh euter behandelt Stockfotohttps://www.alamy.de/image-license-details/?v=1https://www.alamy.de/prinzipien-und-praxis-von-butter-eine-abhandlung-uber-die-chemischen-und-physikalischen-eigenschaften-von-milch-und-seine-komponenten-dem-umgang-mit-milch-und-sahne-und-die-herstellung-von-butter-davon-butter-und-milch-gart-in-der-milch-51-wird-eine-reihe-von-arten-die-dieser-gruppe-angehoren-die-patho-transgene-keime-oder-krankheit-produzierende-bakterien-muss-auch-mit-den-schadlichen-bakterien-eingestuft-werden-es-ist-nicht-die-absicht-die-in-dieser-arbeit-eine-langere-debatte-uber-dieses-thema-zu-geben-fur-eine-solche-diskussion-siehe-besondere-werke-auf-molkerei-bakteriologie-tanne-10-shows-platte-ausgesetzt-eine-halbe-minute-unter-der-kuh-euter-behandelt-image232335493.htmlRMRDYP85–. Prinzipien und Praxis von Butter; eine Abhandlung über die chemischen und physikalischen Eigenschaften von Milch und seine Komponenten, dem Umgang mit Milch und Sahne, und die Herstellung von Butter davon. Butter und Milch. Gärt IN DER MILCH. 51 wird eine Reihe von Arten, die dieser Gruppe angehören. Die patho-transgene Keime, oder Krankheit-produzierende Bakterien, muss auch mit den schädlichen Bakterien eingestuft werden. Es ist nicht die Absicht, die in dieser Arbeit eine längere Debatte über dieses Thema zu geben. Für eine solche Diskussion siehe besondere Werke auf Molkerei Bakteriologie.. Tanne,. 10. âShows Platte ausgesetzt eine halbe Minute unter der kuh euter behandelt
 . Beurteilung der Nutztiere. Viehbestand. Kapitel X. BEURTEILUNG PFERDE OP-KABELBAUM TYP. In der Diskussion über den Entwurf des Pferdes in den vorangegangenen Seiten, viele Dinge sind im Detail betrachtet, die eine allgemeine Anwendung für alle Arten von Pferden, und müssen nicht er wieder aufgegriffen. Daher ist es höchst desirahle, dass der Leser sich mit dem Gegenstand der Beurteilung von Zugpferden vertraut machen. Der Schwerpunkt wird auf den folgenden Seiten auf jene Funktionen, die spezielle Anwendungen platziert werden, um den Typ unter Berücksichtigung. Im Vergleich den Scheinwerferkabelbaum Pferd ist viel kleiner als der Entwurf des Pferdes, Stockfotohttps://www.alamy.de/image-license-details/?v=1https://www.alamy.de/beurteilung-der-nutztiere-viehbestand-kapitel-x-beurteilung-pferde-op-kabelbaum-typ-in-der-diskussion-uber-den-entwurf-des-pferdes-in-den-vorangegangenen-seiten-viele-dinge-sind-im-detail-betrachtet-die-eine-allgemeine-anwendung-fur-alle-arten-von-pferden-und-mussen-nicht-er-wieder-aufgegriffen-daher-ist-es-hochst-desirahle-dass-der-leser-sich-mit-dem-gegenstand-der-beurteilung-von-zugpferden-vertraut-machen-der-schwerpunkt-wird-auf-den-folgenden-seiten-auf-jene-funktionen-die-spezielle-anwendungen-platziert-werden-um-den-typ-unter-berucksichtigung-im-vergleich-den-scheinwerferkabelbaum-pferd-ist-viel-kleiner-als-der-entwurf-des-pferdes-image232316773.html
. Beurteilung der Nutztiere. Viehbestand. Kapitel X. BEURTEILUNG PFERDE OP-KABELBAUM TYP. In der Diskussion über den Entwurf des Pferdes in den vorangegangenen Seiten, viele Dinge sind im Detail betrachtet, die eine allgemeine Anwendung für alle Arten von Pferden, und müssen nicht er wieder aufgegriffen. Daher ist es höchst desirahle, dass der Leser sich mit dem Gegenstand der Beurteilung von Zugpferden vertraut machen. Der Schwerpunkt wird auf den folgenden Seiten auf jene Funktionen, die spezielle Anwendungen platziert werden, um den Typ unter Berücksichtigung. Im Vergleich den Scheinwerferkabelbaum Pferd ist viel kleiner als der Entwurf des Pferdes, Stockfotohttps://www.alamy.de/image-license-details/?v=1https://www.alamy.de/beurteilung-der-nutztiere-viehbestand-kapitel-x-beurteilung-pferde-op-kabelbaum-typ-in-der-diskussion-uber-den-entwurf-des-pferdes-in-den-vorangegangenen-seiten-viele-dinge-sind-im-detail-betrachtet-die-eine-allgemeine-anwendung-fur-alle-arten-von-pferden-und-mussen-nicht-er-wieder-aufgegriffen-daher-ist-es-hochst-desirahle-dass-der-leser-sich-mit-dem-gegenstand-der-beurteilung-von-zugpferden-vertraut-machen-der-schwerpunkt-wird-auf-den-folgenden-seiten-auf-jene-funktionen-die-spezielle-anwendungen-platziert-werden-um-den-typ-unter-berucksichtigung-im-vergleich-den-scheinwerferkabelbaum-pferd-ist-viel-kleiner-als-der-entwurf-des-pferdes-image232316773.htmlRMRDXXBH–. Beurteilung der Nutztiere. Viehbestand. Kapitel X. BEURTEILUNG PFERDE OP-KABELBAUM TYP. In der Diskussion über den Entwurf des Pferdes in den vorangegangenen Seiten, viele Dinge sind im Detail betrachtet, die eine allgemeine Anwendung für alle Arten von Pferden, und müssen nicht er wieder aufgegriffen. Daher ist es höchst desirahle, dass der Leser sich mit dem Gegenstand der Beurteilung von Zugpferden vertraut machen. Der Schwerpunkt wird auf den folgenden Seiten auf jene Funktionen, die spezielle Anwendungen platziert werden, um den Typ unter Berücksichtigung. Im Vergleich den Scheinwerferkabelbaum Pferd ist viel kleiner als der Entwurf des Pferdes,
 . Beiträge der botanischen Labor und der Morris Arboretum der Universität von Pennsylvania, Vol. 14. Botanik; Botanik. Aus den Beratungen der Pennsylvania Akademie der Wissenschaft nachgedruckt, Seiten 42-45. Vol.XII, 1938 bemerkenswerte PENNSYLVANIA ORCHIDEEN Edgar T. Wherry Universität von Pennsylvania letztes Jahr gab es eine Diskussion der Farne in Pennsylvania, die von besonderem Interesse für den dis gewesen - in diesem Mitgliedstaat vorgelegt. Eine ähnliche Studie der einheimischen Orchideen ist jetzt angeboten. Aplectrum hyemale (WILLDENOW) Nuttall. Diese Art wurde durch Muhlenberg, kein Zweifel, in Lan gesammelt Stockfotohttps://www.alamy.de/image-license-details/?v=1https://www.alamy.de/beitrage-der-botanischen-labor-und-der-morris-arboretum-der-universitat-von-pennsylvania-vol-14-botanik-botanik-aus-den-beratungen-der-pennsylvania-akademie-der-wissenschaft-nachgedruckt-seiten-42-45-volxii-1938-bemerkenswerte-pennsylvania-orchideen-edgar-t-wherry-universitat-von-pennsylvania-letztes-jahr-gab-es-eine-diskussion-der-farne-in-pennsylvania-die-von-besonderem-interesse-fur-den-dis-gewesen-in-diesem-mitgliedstaat-vorgelegt-eine-ahnliche-studie-der-einheimischen-orchideen-ist-jetzt-angeboten-aplectrum-hyemale-willdenow-nuttall-diese-art-wurde-durch-muhlenberg-kein-zweifel-in-lan-gesammelt-image232553089.html
. Beiträge der botanischen Labor und der Morris Arboretum der Universität von Pennsylvania, Vol. 14. Botanik; Botanik. Aus den Beratungen der Pennsylvania Akademie der Wissenschaft nachgedruckt, Seiten 42-45. Vol.XII, 1938 bemerkenswerte PENNSYLVANIA ORCHIDEEN Edgar T. Wherry Universität von Pennsylvania letztes Jahr gab es eine Diskussion der Farne in Pennsylvania, die von besonderem Interesse für den dis gewesen - in diesem Mitgliedstaat vorgelegt. Eine ähnliche Studie der einheimischen Orchideen ist jetzt angeboten. Aplectrum hyemale (WILLDENOW) Nuttall. Diese Art wurde durch Muhlenberg, kein Zweifel, in Lan gesammelt Stockfotohttps://www.alamy.de/image-license-details/?v=1https://www.alamy.de/beitrage-der-botanischen-labor-und-der-morris-arboretum-der-universitat-von-pennsylvania-vol-14-botanik-botanik-aus-den-beratungen-der-pennsylvania-akademie-der-wissenschaft-nachgedruckt-seiten-42-45-volxii-1938-bemerkenswerte-pennsylvania-orchideen-edgar-t-wherry-universitat-von-pennsylvania-letztes-jahr-gab-es-eine-diskussion-der-farne-in-pennsylvania-die-von-besonderem-interesse-fur-den-dis-gewesen-in-diesem-mitgliedstaat-vorgelegt-eine-ahnliche-studie-der-einheimischen-orchideen-ist-jetzt-angeboten-aplectrum-hyemale-willdenow-nuttall-diese-art-wurde-durch-muhlenberg-kein-zweifel-in-lan-gesammelt-image232553089.htmlRMRE9KRD–. Beiträge der botanischen Labor und der Morris Arboretum der Universität von Pennsylvania, Vol. 14. Botanik; Botanik. Aus den Beratungen der Pennsylvania Akademie der Wissenschaft nachgedruckt, Seiten 42-45. Vol.XII, 1938 bemerkenswerte PENNSYLVANIA ORCHIDEEN Edgar T. Wherry Universität von Pennsylvania letztes Jahr gab es eine Diskussion der Farne in Pennsylvania, die von besonderem Interesse für den dis gewesen - in diesem Mitgliedstaat vorgelegt. Eine ähnliche Studie der einheimischen Orchideen ist jetzt angeboten. Aplectrum hyemale (WILLDENOW) Nuttall. Diese Art wurde durch Muhlenberg, kein Zweifel, in Lan gesammelt
 . Grundlagen der Botanik. Botanik; Botanik. 232 GRUNDLAGEN DER BOTANIK 298. Diskussion. - Fucus ist ein viel mehr hoch entwickelte Anlage als die Blau-grün oder grün Algen in den vorherigen Abschnitten untersucht. Sie verfügt über eine komplette zelluläre Struktur und es gibt erhebliche Arbeitsteilung zwischen den verschiedenen Teilen der Anlage. Es hat einen besonderen Holdfast, Blasen zu dienen als Schwimmer, ^eine haltbare Mittelrippe Run- ning längs der Zweige und sie zu stärken, und erweiterte Ränder der Zweige, Leisten - ing reichlich. Bitte beachten Sie, dass diese Bilder aus gescannten Seite Bilder, die extrahiert werden Stockfotohttps://www.alamy.de/image-license-details/?v=1https://www.alamy.de/grundlagen-der-botanik-botanik-botanik-232-grundlagen-der-botanik-298-diskussion-fucus-ist-ein-viel-mehr-hoch-entwickelte-anlage-als-die-blau-grun-oder-grun-algen-in-den-vorherigen-abschnitten-untersucht-sie-verfugt-uber-eine-komplette-zellulare-struktur-und-es-gibt-erhebliche-arbeitsteilung-zwischen-den-verschiedenen-teilen-der-anlage-es-hat-einen-besonderen-holdfast-blasen-zu-dienen-als-schwimmer-eine-haltbare-mittelrippe-run-ning-langs-der-zweige-und-sie-zu-starken-und-erweiterte-rander-der-zweige-leisten-ing-reichlich-bitte-beachten-sie-dass-diese-bilder-aus-gescannten-seite-bilder-die-extrahiert-werden-image232286526.html
. Grundlagen der Botanik. Botanik; Botanik. 232 GRUNDLAGEN DER BOTANIK 298. Diskussion. - Fucus ist ein viel mehr hoch entwickelte Anlage als die Blau-grün oder grün Algen in den vorherigen Abschnitten untersucht. Sie verfügt über eine komplette zelluläre Struktur und es gibt erhebliche Arbeitsteilung zwischen den verschiedenen Teilen der Anlage. Es hat einen besonderen Holdfast, Blasen zu dienen als Schwimmer, ^eine haltbare Mittelrippe Run- ning längs der Zweige und sie zu stärken, und erweiterte Ränder der Zweige, Leisten - ing reichlich. Bitte beachten Sie, dass diese Bilder aus gescannten Seite Bilder, die extrahiert werden Stockfotohttps://www.alamy.de/image-license-details/?v=1https://www.alamy.de/grundlagen-der-botanik-botanik-botanik-232-grundlagen-der-botanik-298-diskussion-fucus-ist-ein-viel-mehr-hoch-entwickelte-anlage-als-die-blau-grun-oder-grun-algen-in-den-vorherigen-abschnitten-untersucht-sie-verfugt-uber-eine-komplette-zellulare-struktur-und-es-gibt-erhebliche-arbeitsteilung-zwischen-den-verschiedenen-teilen-der-anlage-es-hat-einen-besonderen-holdfast-blasen-zu-dienen-als-schwimmer-eine-haltbare-mittelrippe-run-ning-langs-der-zweige-und-sie-zu-starken-und-erweiterte-rander-der-zweige-leisten-ing-reichlich-bitte-beachten-sie-dass-diese-bilder-aus-gescannten-seite-bilder-die-extrahiert-werden-image232286526.htmlRMRDWFRA–. Grundlagen der Botanik. Botanik; Botanik. 232 GRUNDLAGEN DER BOTANIK 298. Diskussion. - Fucus ist ein viel mehr hoch entwickelte Anlage als die Blau-grün oder grün Algen in den vorherigen Abschnitten untersucht. Sie verfügt über eine komplette zelluläre Struktur und es gibt erhebliche Arbeitsteilung zwischen den verschiedenen Teilen der Anlage. Es hat einen besonderen Holdfast, Blasen zu dienen als Schwimmer, ^eine haltbare Mittelrippe Run- ning längs der Zweige und sie zu stärken, und erweiterte Ränder der Zweige, Leisten - ing reichlich. Bitte beachten Sie, dass diese Bilder aus gescannten Seite Bilder, die extrahiert werden
 . Grundlagen der Botanik. Botanik; Botanik. 232 Grundlagen der Botanik. 298. Diskussion. - Fueus ist ein viel mehr hoch entwickelte Anlage als die Blau-grün oder grün Algen in den vorherigen Abschnitten untersucht. Sie verfügt über eine komplette zelluläre Struktur und es gibt erhebliche Arbeitsteilung zwischen den verschiedenen Teilen der Anlage. Es hat einen besonderen Holdfast, Blasen zu dienen als Schwimmer, ^eine haltbare Mittelrippe Run- ning längs der Zweige und sie zu stärken, und erweiterte Ränder der Zweige, Leisten - ing ausreichend Fläche für die photosyn-vollpanzerung arbeiten. Die äusseren Schichten der Zellen sind insbesondere Stockfotohttps://www.alamy.de/image-license-details/?v=1https://www.alamy.de/grundlagen-der-botanik-botanik-botanik-232-grundlagen-der-botanik-298-diskussion-fueus-ist-ein-viel-mehr-hoch-entwickelte-anlage-als-die-blau-grun-oder-grun-algen-in-den-vorherigen-abschnitten-untersucht-sie-verfugt-uber-eine-komplette-zellulare-struktur-und-es-gibt-erhebliche-arbeitsteilung-zwischen-den-verschiedenen-teilen-der-anlage-es-hat-einen-besonderen-holdfast-blasen-zu-dienen-als-schwimmer-eine-haltbare-mittelrippe-run-ning-langs-der-zweige-und-sie-zu-starken-und-erweiterte-rander-der-zweige-leisten-ing-ausreichend-flache-fur-die-photosyn-vollpanzerung-arbeiten-die-ausseren-schichten-der-zellen-sind-insbesondere-image232080714.html
. Grundlagen der Botanik. Botanik; Botanik. 232 Grundlagen der Botanik. 298. Diskussion. - Fueus ist ein viel mehr hoch entwickelte Anlage als die Blau-grün oder grün Algen in den vorherigen Abschnitten untersucht. Sie verfügt über eine komplette zelluläre Struktur und es gibt erhebliche Arbeitsteilung zwischen den verschiedenen Teilen der Anlage. Es hat einen besonderen Holdfast, Blasen zu dienen als Schwimmer, ^eine haltbare Mittelrippe Run- ning längs der Zweige und sie zu stärken, und erweiterte Ränder der Zweige, Leisten - ing ausreichend Fläche für die photosyn-vollpanzerung arbeiten. Die äusseren Schichten der Zellen sind insbesondere Stockfotohttps://www.alamy.de/image-license-details/?v=1https://www.alamy.de/grundlagen-der-botanik-botanik-botanik-232-grundlagen-der-botanik-298-diskussion-fueus-ist-ein-viel-mehr-hoch-entwickelte-anlage-als-die-blau-grun-oder-grun-algen-in-den-vorherigen-abschnitten-untersucht-sie-verfugt-uber-eine-komplette-zellulare-struktur-und-es-gibt-erhebliche-arbeitsteilung-zwischen-den-verschiedenen-teilen-der-anlage-es-hat-einen-besonderen-holdfast-blasen-zu-dienen-als-schwimmer-eine-haltbare-mittelrippe-run-ning-langs-der-zweige-und-sie-zu-starken-und-erweiterte-rander-der-zweige-leisten-ing-ausreichend-flache-fur-die-photosyn-vollpanzerung-arbeiten-die-ausseren-schichten-der-zellen-sind-insbesondere-image232080714.htmlRMRDG58X–. Grundlagen der Botanik. Botanik; Botanik. 232 Grundlagen der Botanik. 298. Diskussion. - Fueus ist ein viel mehr hoch entwickelte Anlage als die Blau-grün oder grün Algen in den vorherigen Abschnitten untersucht. Sie verfügt über eine komplette zelluläre Struktur und es gibt erhebliche Arbeitsteilung zwischen den verschiedenen Teilen der Anlage. Es hat einen besonderen Holdfast, Blasen zu dienen als Schwimmer, ^eine haltbare Mittelrippe Run- ning längs der Zweige und sie zu stärken, und erweiterte Ränder der Zweige, Leisten - ing ausreichend Fläche für die photosyn-vollpanzerung arbeiten. Die äusseren Schichten der Zellen sind insbesondere
 . Das tierische Leben unserer Küste. Mit besonderem Bezug auf die New Jersey Küste und dem südlichen Ufer von Long Island. Meerestiere. Vi. Einige COASTWISE HSIIBS. Amonq die Vorteile und Enden, dass die eingehenden Flut wirft auf den Strand sind die eigenartigen Kissen - geformte Objekte mit Langwierigen Ecken, die allgemein unter dem Namen der EA-Geldbörsen bekannt sind." Groß ist die Diskussion die Teilnahme an der Suche nach einer dieser Meer - Geldbörsen, und viele sind die Vermutungen über deren wahre Natur. Die Exemplare gefunden auf dem Sand sind in der Regel trocken und im Geldbeutel Teil split, nichts angezeigt innerhalb;. Die Stockfotohttps://www.alamy.de/image-license-details/?v=1https://www.alamy.de/das-tierische-leben-unserer-kuste-mit-besonderem-bezug-auf-die-new-jersey-kuste-und-dem-sudlichen-ufer-von-long-island-meerestiere-vi-einige-coastwise-hsiibs-amonq-die-vorteile-und-enden-dass-die-eingehenden-flut-wirft-auf-den-strand-sind-die-eigenartigen-kissen-geformte-objekte-mit-langwierigen-ecken-die-allgemein-unter-dem-namen-der-ea-geldborsen-bekannt-sind-gross-ist-die-diskussion-die-teilnahme-an-der-suche-nach-einer-dieser-meer-geldborsen-und-viele-sind-die-vermutungen-uber-deren-wahre-natur-die-exemplare-gefunden-auf-dem-sand-sind-in-der-regel-trocken-und-im-geldbeutel-teil-split-nichts-angezeigt-innerhalb-die-image232200264.html
. Das tierische Leben unserer Küste. Mit besonderem Bezug auf die New Jersey Küste und dem südlichen Ufer von Long Island. Meerestiere. Vi. Einige COASTWISE HSIIBS. Amonq die Vorteile und Enden, dass die eingehenden Flut wirft auf den Strand sind die eigenartigen Kissen - geformte Objekte mit Langwierigen Ecken, die allgemein unter dem Namen der EA-Geldbörsen bekannt sind." Groß ist die Diskussion die Teilnahme an der Suche nach einer dieser Meer - Geldbörsen, und viele sind die Vermutungen über deren wahre Natur. Die Exemplare gefunden auf dem Sand sind in der Regel trocken und im Geldbeutel Teil split, nichts angezeigt innerhalb;. Die Stockfotohttps://www.alamy.de/image-license-details/?v=1https://www.alamy.de/das-tierische-leben-unserer-kuste-mit-besonderem-bezug-auf-die-new-jersey-kuste-und-dem-sudlichen-ufer-von-long-island-meerestiere-vi-einige-coastwise-hsiibs-amonq-die-vorteile-und-enden-dass-die-eingehenden-flut-wirft-auf-den-strand-sind-die-eigenartigen-kissen-geformte-objekte-mit-langwierigen-ecken-die-allgemein-unter-dem-namen-der-ea-geldborsen-bekannt-sind-gross-ist-die-diskussion-die-teilnahme-an-der-suche-nach-einer-dieser-meer-geldborsen-und-viele-sind-die-vermutungen-uber-deren-wahre-natur-die-exemplare-gefunden-auf-dem-sand-sind-in-der-regel-trocken-und-im-geldbeutel-teil-split-nichts-angezeigt-innerhalb-die-image232200264.htmlRMRDNHPG–. Das tierische Leben unserer Küste. Mit besonderem Bezug auf die New Jersey Küste und dem südlichen Ufer von Long Island. Meerestiere. Vi. Einige COASTWISE HSIIBS. Amonq die Vorteile und Enden, dass die eingehenden Flut wirft auf den Strand sind die eigenartigen Kissen - geformte Objekte mit Langwierigen Ecken, die allgemein unter dem Namen der EA-Geldbörsen bekannt sind." Groß ist die Diskussion die Teilnahme an der Suche nach einer dieser Meer - Geldbörsen, und viele sind die Vermutungen über deren wahre Natur. Die Exemplare gefunden auf dem Sand sind in der Regel trocken und im Geldbeutel Teil split, nichts angezeigt innerhalb;. Die
 . Imkerei, eine Diskussion über das Leben der Honigbiene und der Produktion von Honig. Bienen und Honig. Abb. 29. - Tool-box Sitz. Bienen. Ein Bienenstock Abdeckung auf Kante macht einen guten temporären Sitz und hat die Ad-Vantage. Von dort zu sein, wo es gebraucht wird, andwhen erforderlich ist sonst nicht oc-cupied. Andere Geräte. Es gibt einige zusätzliche Hilfsmittel, die verwendet werden dürfen - ful in einem Bienenhaus, die kurz erwähnt werden. Für die Änderungen in der Versorgung und bei der Entwicklung von Teilen für besondere Verwendungszwecke, die imkerei Anlagen sollten einige Tischler Tools, unter denen Hämmer genannt werden kann, Sägen (einschließlich ein Schlüsselloch gehören Stockfotohttps://www.alamy.de/image-license-details/?v=1https://www.alamy.de/imkerei-eine-diskussion-uber-das-leben-der-honigbiene-und-der-produktion-von-honig-bienen-und-honig-abb-29-tool-box-sitz-bienen-ein-bienenstock-abdeckung-auf-kante-macht-einen-guten-temporaren-sitz-und-hat-die-ad-vantage-von-dort-zu-sein-wo-es-gebraucht-wird-andwhen-erforderlich-ist-sonst-nicht-oc-cupied-andere-gerate-es-gibt-einige-zusatzliche-hilfsmittel-die-verwendet-werden-durfen-ful-in-einem-bienenhaus-die-kurz-erwahnt-werden-fur-die-anderungen-in-der-versorgung-und-bei-der-entwicklung-von-teilen-fur-besondere-verwendungszwecke-die-imkerei-anlagen-sollten-einige-tischler-tools-unter-denen-hammer-genannt-werden-kann-sagen-einschliesslich-ein-schlusselloch-gehoren-image232062285.html
. Imkerei, eine Diskussion über das Leben der Honigbiene und der Produktion von Honig. Bienen und Honig. Abb. 29. - Tool-box Sitz. Bienen. Ein Bienenstock Abdeckung auf Kante macht einen guten temporären Sitz und hat die Ad-Vantage. Von dort zu sein, wo es gebraucht wird, andwhen erforderlich ist sonst nicht oc-cupied. Andere Geräte. Es gibt einige zusätzliche Hilfsmittel, die verwendet werden dürfen - ful in einem Bienenhaus, die kurz erwähnt werden. Für die Änderungen in der Versorgung und bei der Entwicklung von Teilen für besondere Verwendungszwecke, die imkerei Anlagen sollten einige Tischler Tools, unter denen Hämmer genannt werden kann, Sägen (einschließlich ein Schlüsselloch gehören Stockfotohttps://www.alamy.de/image-license-details/?v=1https://www.alamy.de/imkerei-eine-diskussion-uber-das-leben-der-honigbiene-und-der-produktion-von-honig-bienen-und-honig-abb-29-tool-box-sitz-bienen-ein-bienenstock-abdeckung-auf-kante-macht-einen-guten-temporaren-sitz-und-hat-die-ad-vantage-von-dort-zu-sein-wo-es-gebraucht-wird-andwhen-erforderlich-ist-sonst-nicht-oc-cupied-andere-gerate-es-gibt-einige-zusatzliche-hilfsmittel-die-verwendet-werden-durfen-ful-in-einem-bienenhaus-die-kurz-erwahnt-werden-fur-die-anderungen-in-der-versorgung-und-bei-der-entwicklung-von-teilen-fur-besondere-verwendungszwecke-die-imkerei-anlagen-sollten-einige-tischler-tools-unter-denen-hammer-genannt-werden-kann-sagen-einschliesslich-ein-schlusselloch-gehoren-image232062285.htmlRMRDF9PN–. Imkerei, eine Diskussion über das Leben der Honigbiene und der Produktion von Honig. Bienen und Honig. Abb. 29. - Tool-box Sitz. Bienen. Ein Bienenstock Abdeckung auf Kante macht einen guten temporären Sitz und hat die Ad-Vantage. Von dort zu sein, wo es gebraucht wird, andwhen erforderlich ist sonst nicht oc-cupied. Andere Geräte. Es gibt einige zusätzliche Hilfsmittel, die verwendet werden dürfen - ful in einem Bienenhaus, die kurz erwähnt werden. Für die Änderungen in der Versorgung und bei der Entwicklung von Teilen für besondere Verwendungszwecke, die imkerei Anlagen sollten einige Tischler Tools, unter denen Hämmer genannt werden kann, Sägen (einschließlich ein Schlüsselloch gehören
 . Ein Labor Handbuch des Bodens Bakteriologie. Bodenmikrobiologie. Kapitel XI Besondere Methoden für eine ausführliche Diskussion der Sterilisation siehe eines der Standardwerke auf bakteriologische Technic. Hier nur spezielle Phasen dieses Thema berücksichtigt werden. Seed Sterilisation.-^ Obwohl eine große Anzahl von Methoden mit verschiedenen Agenten haben für das Entfernen der Mikro-organismen empfohlen worden, die aus Saatgut, um nur einige der viel versprechenden, werden gegeben. Wo Es ist nicht erforderlich die Samen frei von Bakterien zu machen, sondern lediglich die Mehrheit der Flora zu zerstören, kann Alkohol verwendet werden. Abb. Ii - Apparatu Stockfotohttps://www.alamy.de/image-license-details/?v=1https://www.alamy.de/ein-labor-handbuch-des-bodens-bakteriologie-bodenmikrobiologie-kapitel-xi-besondere-methoden-fur-eine-ausfuhrliche-diskussion-der-sterilisation-siehe-eines-der-standardwerke-auf-bakteriologische-technic-hier-nur-spezielle-phasen-dieses-thema-berucksichtigt-werden-seed-sterilisation-obwohl-eine-grosse-anzahl-von-methoden-mit-verschiedenen-agenten-haben-fur-das-entfernen-der-mikro-organismen-empfohlen-worden-die-aus-saatgut-um-nur-einige-der-viel-versprechenden-werden-gegeben-wo-es-ist-nicht-erforderlich-die-samen-frei-von-bakterien-zu-machen-sondern-lediglich-die-mehrheit-der-flora-zu-zerstoren-kann-alkohol-verwendet-werden-abb-ii-apparatu-image231921538.html
. Ein Labor Handbuch des Bodens Bakteriologie. Bodenmikrobiologie. Kapitel XI Besondere Methoden für eine ausführliche Diskussion der Sterilisation siehe eines der Standardwerke auf bakteriologische Technic. Hier nur spezielle Phasen dieses Thema berücksichtigt werden. Seed Sterilisation.-^ Obwohl eine große Anzahl von Methoden mit verschiedenen Agenten haben für das Entfernen der Mikro-organismen empfohlen worden, die aus Saatgut, um nur einige der viel versprechenden, werden gegeben. Wo Es ist nicht erforderlich die Samen frei von Bakterien zu machen, sondern lediglich die Mehrheit der Flora zu zerstören, kann Alkohol verwendet werden. Abb. Ii - Apparatu Stockfotohttps://www.alamy.de/image-license-details/?v=1https://www.alamy.de/ein-labor-handbuch-des-bodens-bakteriologie-bodenmikrobiologie-kapitel-xi-besondere-methoden-fur-eine-ausfuhrliche-diskussion-der-sterilisation-siehe-eines-der-standardwerke-auf-bakteriologische-technic-hier-nur-spezielle-phasen-dieses-thema-berucksichtigt-werden-seed-sterilisation-obwohl-eine-grosse-anzahl-von-methoden-mit-verschiedenen-agenten-haben-fur-das-entfernen-der-mikro-organismen-empfohlen-worden-die-aus-saatgut-um-nur-einige-der-viel-versprechenden-werden-gegeben-wo-es-ist-nicht-erforderlich-die-samen-frei-von-bakterien-zu-machen-sondern-lediglich-die-mehrheit-der-flora-zu-zerstoren-kann-alkohol-verwendet-werden-abb-ii-apparatu-image231921538.htmlRMRD8X82–. Ein Labor Handbuch des Bodens Bakteriologie. Bodenmikrobiologie. Kapitel XI Besondere Methoden für eine ausführliche Diskussion der Sterilisation siehe eines der Standardwerke auf bakteriologische Technic. Hier nur spezielle Phasen dieses Thema berücksichtigt werden. Seed Sterilisation.-^ Obwohl eine große Anzahl von Methoden mit verschiedenen Agenten haben für das Entfernen der Mikro-organismen empfohlen worden, die aus Saatgut, um nur einige der viel versprechenden, werden gegeben. Wo Es ist nicht erforderlich die Samen frei von Bakterien zu machen, sondern lediglich die Mehrheit der Flora zu zerstören, kann Alkohol verwendet werden. Abb. Ii - Apparatu
 . Imkerei, eine Diskussion über das Leben der Honigbiene und der Produktion von Honig. Bienen und Honig. 32 Bienenhaltung. Abb. 29. - Tool-box Sitz. Bienen. Ein Bienenstock Abdeckung auf Kante macht einen guten temporären Sitz und hat die Ad-Vantage. Von dort zu sein, wo es gebraucht wird, andwhen erforderlich ist sonst nicht oc-cupied. Andere Geräte. Es gibt einige zusätzliche Hilfsmittel, die verwendet werden dürfen - ful in einem Bienenhaus, die kurz erwähnt werden. Für die Änderungen in der Versorgung und bei der Entwicklung von Teilen für besondere Verwendungszwecke, die imkerei Anlagen sollten einige Tischler Tools, unter denen Hämmer genannt werden kann, Sägen (inclu gehören Stockfotohttps://www.alamy.de/image-license-details/?v=1https://www.alamy.de/imkerei-eine-diskussion-uber-das-leben-der-honigbiene-und-der-produktion-von-honig-bienen-und-honig-32-bienenhaltung-abb-29-tool-box-sitz-bienen-ein-bienenstock-abdeckung-auf-kante-macht-einen-guten-temporaren-sitz-und-hat-die-ad-vantage-von-dort-zu-sein-wo-es-gebraucht-wird-andwhen-erforderlich-ist-sonst-nicht-oc-cupied-andere-gerate-es-gibt-einige-zusatzliche-hilfsmittel-die-verwendet-werden-durfen-ful-in-einem-bienenhaus-die-kurz-erwahnt-werden-fur-die-anderungen-in-der-versorgung-und-bei-der-entwicklung-von-teilen-fur-besondere-verwendungszwecke-die-imkerei-anlagen-sollten-einige-tischler-tools-unter-denen-hammer-genannt-werden-kann-sagen-inclu-gehoren-image232062296.html
. Imkerei, eine Diskussion über das Leben der Honigbiene und der Produktion von Honig. Bienen und Honig. 32 Bienenhaltung. Abb. 29. - Tool-box Sitz. Bienen. Ein Bienenstock Abdeckung auf Kante macht einen guten temporären Sitz und hat die Ad-Vantage. Von dort zu sein, wo es gebraucht wird, andwhen erforderlich ist sonst nicht oc-cupied. Andere Geräte. Es gibt einige zusätzliche Hilfsmittel, die verwendet werden dürfen - ful in einem Bienenhaus, die kurz erwähnt werden. Für die Änderungen in der Versorgung und bei der Entwicklung von Teilen für besondere Verwendungszwecke, die imkerei Anlagen sollten einige Tischler Tools, unter denen Hämmer genannt werden kann, Sägen (inclu gehören Stockfotohttps://www.alamy.de/image-license-details/?v=1https://www.alamy.de/imkerei-eine-diskussion-uber-das-leben-der-honigbiene-und-der-produktion-von-honig-bienen-und-honig-32-bienenhaltung-abb-29-tool-box-sitz-bienen-ein-bienenstock-abdeckung-auf-kante-macht-einen-guten-temporaren-sitz-und-hat-die-ad-vantage-von-dort-zu-sein-wo-es-gebraucht-wird-andwhen-erforderlich-ist-sonst-nicht-oc-cupied-andere-gerate-es-gibt-einige-zusatzliche-hilfsmittel-die-verwendet-werden-durfen-ful-in-einem-bienenhaus-die-kurz-erwahnt-werden-fur-die-anderungen-in-der-versorgung-und-bei-der-entwicklung-von-teilen-fur-besondere-verwendungszwecke-die-imkerei-anlagen-sollten-einige-tischler-tools-unter-denen-hammer-genannt-werden-kann-sagen-inclu-gehoren-image232062296.htmlRMRDF9R4–. Imkerei, eine Diskussion über das Leben der Honigbiene und der Produktion von Honig. Bienen und Honig. 32 Bienenhaltung. Abb. 29. - Tool-box Sitz. Bienen. Ein Bienenstock Abdeckung auf Kante macht einen guten temporären Sitz und hat die Ad-Vantage. Von dort zu sein, wo es gebraucht wird, andwhen erforderlich ist sonst nicht oc-cupied. Andere Geräte. Es gibt einige zusätzliche Hilfsmittel, die verwendet werden dürfen - ful in einem Bienenhaus, die kurz erwähnt werden. Für die Änderungen in der Versorgung und bei der Entwicklung von Teilen für besondere Verwendungszwecke, die imkerei Anlagen sollten einige Tischler Tools, unter denen Hämmer genannt werden kann, Sägen (inclu gehören
 . Sonderbericht über die Krankheiten der Tiere. Vieh. w Abb. 12-Ei des kurzen Nase blau Laus (Hcematopinus eurysternus) um ein Haar. (Von Bu-reau Entomologie.) Rinder sind vier Arten von räude, die gemeinsame Räude oder psoroptic Räude der wichtigste ist. Psoroptic mange von Rindern ist von einer Art von kleinen Milben (Abb. verursacht. 13), Multi-Abb. 11.- Rote Laus (Trichodectes scalaris) von Rindern. (Von Bu-reau Entomologie.)" für eine ausführlichere Diskussion siehe Landwirte Bulletin 152, durch das Landwirtschaftsministerium der Vereinigten Staaten von Amerika erteilt. Bitte beachten Sie, dass diese Bilder extrac sind Stockfotohttps://www.alamy.de/image-license-details/?v=1https://www.alamy.de/sonderbericht-uber-die-krankheiten-der-tiere-vieh-w-abb-12-ei-des-kurzen-nase-blau-laus-hcematopinus-eurysternus-um-ein-haar-von-bu-reau-entomologie-rinder-sind-vier-arten-von-raude-die-gemeinsame-raude-oder-psoroptic-raude-der-wichtigste-ist-psoroptic-mange-von-rindern-ist-von-einer-art-von-kleinen-milben-abb-verursacht-13-multi-abb-11-rote-laus-trichodectes-scalaris-von-rindern-von-bu-reau-entomologie-fur-eine-ausfuhrlichere-diskussion-siehe-landwirte-bulletin-152-durch-das-landwirtschaftsministerium-der-vereinigten-staaten-von-amerika-erteilt-bitte-beachten-sie-dass-diese-bilder-extrac-sind-image232423959.html
. Sonderbericht über die Krankheiten der Tiere. Vieh. w Abb. 12-Ei des kurzen Nase blau Laus (Hcematopinus eurysternus) um ein Haar. (Von Bu-reau Entomologie.) Rinder sind vier Arten von räude, die gemeinsame Räude oder psoroptic Räude der wichtigste ist. Psoroptic mange von Rindern ist von einer Art von kleinen Milben (Abb. verursacht. 13), Multi-Abb. 11.- Rote Laus (Trichodectes scalaris) von Rindern. (Von Bu-reau Entomologie.)" für eine ausführlichere Diskussion siehe Landwirte Bulletin 152, durch das Landwirtschaftsministerium der Vereinigten Staaten von Amerika erteilt. Bitte beachten Sie, dass diese Bilder extrac sind Stockfotohttps://www.alamy.de/image-license-details/?v=1https://www.alamy.de/sonderbericht-uber-die-krankheiten-der-tiere-vieh-w-abb-12-ei-des-kurzen-nase-blau-laus-hcematopinus-eurysternus-um-ein-haar-von-bu-reau-entomologie-rinder-sind-vier-arten-von-raude-die-gemeinsame-raude-oder-psoroptic-raude-der-wichtigste-ist-psoroptic-mange-von-rindern-ist-von-einer-art-von-kleinen-milben-abb-verursacht-13-multi-abb-11-rote-laus-trichodectes-scalaris-von-rindern-von-bu-reau-entomologie-fur-eine-ausfuhrlichere-diskussion-siehe-landwirte-bulletin-152-durch-das-landwirtschaftsministerium-der-vereinigten-staaten-von-amerika-erteilt-bitte-beachten-sie-dass-diese-bilder-extrac-sind-image232423959.htmlRMRE3R3K–. Sonderbericht über die Krankheiten der Tiere. Vieh. w Abb. 12-Ei des kurzen Nase blau Laus (Hcematopinus eurysternus) um ein Haar. (Von Bu-reau Entomologie.) Rinder sind vier Arten von räude, die gemeinsame Räude oder psoroptic Räude der wichtigste ist. Psoroptic mange von Rindern ist von einer Art von kleinen Milben (Abb. verursacht. 13), Multi-Abb. 11.- Rote Laus (Trichodectes scalaris) von Rindern. (Von Bu-reau Entomologie.)" für eine ausführlichere Diskussion siehe Landwirte Bulletin 152, durch das Landwirtschaftsministerium der Vereinigten Staaten von Amerika erteilt. Bitte beachten Sie, dass diese Bilder extrac sind
 . Die Maisernte: Eine Diskussion von Mais, Sorghum, kafirs und wie in den USA und Kanada angebaut. Mais; Kafir Mais, Sorghum. Ackerbau 125 Maisstengeln, und Klee waren alle unter gepflügt, und dieses System wurde als "Getreideanbau" da keine live stock Dünger zu produzieren war erforderlich.. Abb. 38. - Gutes Land, kontinuierlich mit Korn beschnitten, bis Sie in einen unproduktiven Zustand ist. In einer zweiten Serie, bezeichnet "live - Viehzucht, "die Ernten wurden entfernt, jedoch gleichwertige Dünger zurück. Erntegut Jahre spezielle Behandlung Korn Landwirtschaft Leguminosen^ Live - Viehzucht Ma Stockfotohttps://www.alamy.de/image-license-details/?v=1https://www.alamy.de/die-maisernte-eine-diskussion-von-mais-sorghum-kafirs-und-wie-in-den-usa-und-kanada-angebaut-mais-kafir-mais-sorghum-ackerbau-125-maisstengeln-und-klee-waren-alle-unter-gepflugt-und-dieses-system-wurde-als-getreideanbau-da-keine-live-stock-dunger-zu-produzieren-war-erforderlich-abb-38-gutes-land-kontinuierlich-mit-korn-beschnitten-bis-sie-in-einen-unproduktiven-zustand-ist-in-einer-zweiten-serie-bezeichnet-live-viehzucht-die-ernten-wurden-entfernt-jedoch-gleichwertige-dunger-zuruck-erntegut-jahre-spezielle-behandlung-korn-landwirtschaft-leguminosen-live-viehzucht-ma-image232061141.html
. Die Maisernte: Eine Diskussion von Mais, Sorghum, kafirs und wie in den USA und Kanada angebaut. Mais; Kafir Mais, Sorghum. Ackerbau 125 Maisstengeln, und Klee waren alle unter gepflügt, und dieses System wurde als "Getreideanbau" da keine live stock Dünger zu produzieren war erforderlich.. Abb. 38. - Gutes Land, kontinuierlich mit Korn beschnitten, bis Sie in einen unproduktiven Zustand ist. In einer zweiten Serie, bezeichnet "live - Viehzucht, "die Ernten wurden entfernt, jedoch gleichwertige Dünger zurück. Erntegut Jahre spezielle Behandlung Korn Landwirtschaft Leguminosen^ Live - Viehzucht Ma Stockfotohttps://www.alamy.de/image-license-details/?v=1https://www.alamy.de/die-maisernte-eine-diskussion-von-mais-sorghum-kafirs-und-wie-in-den-usa-und-kanada-angebaut-mais-kafir-mais-sorghum-ackerbau-125-maisstengeln-und-klee-waren-alle-unter-gepflugt-und-dieses-system-wurde-als-getreideanbau-da-keine-live-stock-dunger-zu-produzieren-war-erforderlich-abb-38-gutes-land-kontinuierlich-mit-korn-beschnitten-bis-sie-in-einen-unproduktiven-zustand-ist-in-einer-zweiten-serie-bezeichnet-live-viehzucht-die-ernten-wurden-entfernt-jedoch-gleichwertige-dunger-zuruck-erntegut-jahre-spezielle-behandlung-korn-landwirtschaft-leguminosen-live-viehzucht-ma-image232061141.htmlRMRDF89W–. Die Maisernte: Eine Diskussion von Mais, Sorghum, kafirs und wie in den USA und Kanada angebaut. Mais; Kafir Mais, Sorghum. Ackerbau 125 Maisstengeln, und Klee waren alle unter gepflügt, und dieses System wurde als "Getreideanbau" da keine live stock Dünger zu produzieren war erforderlich.. Abb. 38. - Gutes Land, kontinuierlich mit Korn beschnitten, bis Sie in einen unproduktiven Zustand ist. In einer zweiten Serie, bezeichnet "live - Viehzucht, "die Ernten wurden entfernt, jedoch gleichwertige Dünger zurück. Erntegut Jahre spezielle Behandlung Korn Landwirtschaft Leguminosen^ Live - Viehzucht Ma
 . Die Maisernte: Eine Diskussion von Mais, Sorghum, kafirs und wie in den USA und Kanada angebaut. Mais; Kafir Mais, Sorghum. Abb. 49. - Spezielle Anlagen für Mais Pflanzmaschine Schuhe. Im Mai gepflanzt war 73 Bushel pro Acre, während der durchschnittliche Ertrag der drei verbleibenden Anpflanzungen, einer im April und zwei im Juni, war 63 Bushel pro Acre. Manjr Experimente an anderen Stationen tragen Sie die Aussage, dass es einen Zeitraum von etwa drei Wochen für Mais anpflanzen mit gleichen Chancen auf Erfolg, aber es gibt gelegentlich Jahreszeiten, wenn die sehr früh oder sehr spät Anlage- nungen sind am besten. Die optimale Jahreszeit Stockfotohttps://www.alamy.de/image-license-details/?v=1https://www.alamy.de/die-maisernte-eine-diskussion-von-mais-sorghum-kafirs-und-wie-in-den-usa-und-kanada-angebaut-mais-kafir-mais-sorghum-abb-49-spezielle-anlagen-fur-mais-pflanzmaschine-schuhe-im-mai-gepflanzt-war-73-bushel-pro-acre-wahrend-der-durchschnittliche-ertrag-der-drei-verbleibenden-anpflanzungen-einer-im-april-und-zwei-im-juni-war-63-bushel-pro-acre-manjr-experimente-an-anderen-stationen-tragen-sie-die-aussage-dass-es-einen-zeitraum-von-etwa-drei-wochen-fur-mais-anpflanzen-mit-gleichen-chancen-auf-erfolg-aber-es-gibt-gelegentlich-jahreszeiten-wenn-die-sehr-fruh-oder-sehr-spat-anlage-nungen-sind-am-besten-die-optimale-jahreszeit-image232060982.html
. Die Maisernte: Eine Diskussion von Mais, Sorghum, kafirs und wie in den USA und Kanada angebaut. Mais; Kafir Mais, Sorghum. Abb. 49. - Spezielle Anlagen für Mais Pflanzmaschine Schuhe. Im Mai gepflanzt war 73 Bushel pro Acre, während der durchschnittliche Ertrag der drei verbleibenden Anpflanzungen, einer im April und zwei im Juni, war 63 Bushel pro Acre. Manjr Experimente an anderen Stationen tragen Sie die Aussage, dass es einen Zeitraum von etwa drei Wochen für Mais anpflanzen mit gleichen Chancen auf Erfolg, aber es gibt gelegentlich Jahreszeiten, wenn die sehr früh oder sehr spät Anlage- nungen sind am besten. Die optimale Jahreszeit Stockfotohttps://www.alamy.de/image-license-details/?v=1https://www.alamy.de/die-maisernte-eine-diskussion-von-mais-sorghum-kafirs-und-wie-in-den-usa-und-kanada-angebaut-mais-kafir-mais-sorghum-abb-49-spezielle-anlagen-fur-mais-pflanzmaschine-schuhe-im-mai-gepflanzt-war-73-bushel-pro-acre-wahrend-der-durchschnittliche-ertrag-der-drei-verbleibenden-anpflanzungen-einer-im-april-und-zwei-im-juni-war-63-bushel-pro-acre-manjr-experimente-an-anderen-stationen-tragen-sie-die-aussage-dass-es-einen-zeitraum-von-etwa-drei-wochen-fur-mais-anpflanzen-mit-gleichen-chancen-auf-erfolg-aber-es-gibt-gelegentlich-jahreszeiten-wenn-die-sehr-fruh-oder-sehr-spat-anlage-nungen-sind-am-besten-die-optimale-jahreszeit-image232060982.htmlRMRDF846–. Die Maisernte: Eine Diskussion von Mais, Sorghum, kafirs und wie in den USA und Kanada angebaut. Mais; Kafir Mais, Sorghum. Abb. 49. - Spezielle Anlagen für Mais Pflanzmaschine Schuhe. Im Mai gepflanzt war 73 Bushel pro Acre, während der durchschnittliche Ertrag der drei verbleibenden Anpflanzungen, einer im April und zwei im Juni, war 63 Bushel pro Acre. Manjr Experimente an anderen Stationen tragen Sie die Aussage, dass es einen Zeitraum von etwa drei Wochen für Mais anpflanzen mit gleichen Chancen auf Erfolg, aber es gibt gelegentlich Jahreszeiten, wenn die sehr früh oder sehr spät Anlage- nungen sind am besten. Die optimale Jahreszeit
![. Die Armee-worm [microform]: Cirphus (leucania) unipuncta Haw.. (Légionnaires Chenilles); Insectes nuisibles; Schädlinge; Armee - Worms. 23 Hulk der Kulturpflanzen. Als outbroak wurde hpcoming umfangreicher Ami ernster, eine Sondersitzung des County Council wurde im Rathaus in Brantford, um die Situation zu besprechen, und die meisten effir='nt Methoden der Kontrolle. Wandte ich mich an den Rat, zur Festlegung besonderer Nachdruck auf prompte und Co-opera-tion, während Herr Schuyler aus den schwerwiegenden Mangel an Hilfe mit der Invasion zu bewältigen. Nach einer kurzen Diskussion, geführt von Herrn Fischer, M.P. Stockfoto . Die Armee-worm [microform]: Cirphus (leucania) unipuncta Haw.. (Légionnaires Chenilles); Insectes nuisibles; Schädlinge; Armee - Worms. 23 Hulk der Kulturpflanzen. Als outbroak wurde hpcoming umfangreicher Ami ernster, eine Sondersitzung des County Council wurde im Rathaus in Brantford, um die Situation zu besprechen, und die meisten effir='nt Methoden der Kontrolle. Wandte ich mich an den Rat, zur Festlegung besonderer Nachdruck auf prompte und Co-opera-tion, während Herr Schuyler aus den schwerwiegenden Mangel an Hilfe mit der Invasion zu bewältigen. Nach einer kurzen Diskussion, geführt von Herrn Fischer, M.P. Stockfoto](https://c8.alamy.com/compde/ren5xa/die-armee-worm-microform-cirphus-leucania-unipuncta-haw-lgionnaires-chenilles-insectes-nuisibles-schadlinge-armee-worms-23-hulk-der-kulturpflanzen-als-outbroak-wurde-hpcoming-umfangreicher-ami-ernster-eine-sondersitzung-des-county-council-wurde-im-rathaus-in-brantford-um-die-situation-zu-besprechen-und-die-meisten-effir=nt-methoden-der-kontrolle-wandte-ich-mich-an-den-rat-zur-festlegung-besonderer-nachdruck-auf-prompte-und-co-opera-tion-wahrend-herr-schuyler-aus-den-schwerwiegenden-mangel-an-hilfe-mit-der-invasion-zu-bewaltigen-nach-einer-kurzen-diskussion-gefuhrt-von-herrn-fischer-mp-ren5xa.jpg) . Die Armee-worm [microform]: Cirphus (leucania) unipuncta Haw.. (Légionnaires Chenilles); Insectes nuisibles; Schädlinge; Armee - Worms. 23 Hulk der Kulturpflanzen. Als outbroak wurde hpcoming umfangreicher Ami ernster, eine Sondersitzung des County Council wurde im Rathaus in Brantford, um die Situation zu besprechen, und die meisten effir='nt Methoden der Kontrolle. Wandte ich mich an den Rat, zur Festlegung besonderer Nachdruck auf prompte und Co-opera-tion, während Herr Schuyler aus den schwerwiegenden Mangel an Hilfe mit der Invasion zu bewältigen. Nach einer kurzen Diskussion, geführt von Herrn Fischer, M.P. Stockfotohttps://www.alamy.de/image-license-details/?v=1https://www.alamy.de/die-armee-worm-microform-cirphus-leucania-unipuncta-haw-lgionnaires-chenilles-insectes-nuisibles-schadlinge-armee-worms-23-hulk-der-kulturpflanzen-als-outbroak-wurde-hpcoming-umfangreicher-ami-ernster-eine-sondersitzung-des-county-council-wurde-im-rathaus-in-brantford-um-die-situation-zu-besprechen-und-die-meisten-effir=nt-methoden-der-kontrolle-wandte-ich-mich-an-den-rat-zur-festlegung-besonderer-nachdruck-auf-prompte-und-co-opera-tion-wahrend-herr-schuyler-aus-den-schwerwiegenden-mangel-an-hilfe-mit-der-invasion-zu-bewaltigen-nach-einer-kurzen-diskussion-gefuhrt-von-herrn-fischer-mp-image232805618.html
. Die Armee-worm [microform]: Cirphus (leucania) unipuncta Haw.. (Légionnaires Chenilles); Insectes nuisibles; Schädlinge; Armee - Worms. 23 Hulk der Kulturpflanzen. Als outbroak wurde hpcoming umfangreicher Ami ernster, eine Sondersitzung des County Council wurde im Rathaus in Brantford, um die Situation zu besprechen, und die meisten effir='nt Methoden der Kontrolle. Wandte ich mich an den Rat, zur Festlegung besonderer Nachdruck auf prompte und Co-opera-tion, während Herr Schuyler aus den schwerwiegenden Mangel an Hilfe mit der Invasion zu bewältigen. Nach einer kurzen Diskussion, geführt von Herrn Fischer, M.P. Stockfotohttps://www.alamy.de/image-license-details/?v=1https://www.alamy.de/die-armee-worm-microform-cirphus-leucania-unipuncta-haw-lgionnaires-chenilles-insectes-nuisibles-schadlinge-armee-worms-23-hulk-der-kulturpflanzen-als-outbroak-wurde-hpcoming-umfangreicher-ami-ernster-eine-sondersitzung-des-county-council-wurde-im-rathaus-in-brantford-um-die-situation-zu-besprechen-und-die-meisten-effir=nt-methoden-der-kontrolle-wandte-ich-mich-an-den-rat-zur-festlegung-besonderer-nachdruck-auf-prompte-und-co-opera-tion-wahrend-herr-schuyler-aus-den-schwerwiegenden-mangel-an-hilfe-mit-der-invasion-zu-bewaltigen-nach-einer-kurzen-diskussion-gefuhrt-von-herrn-fischer-mp-image232805618.htmlRMREN5XA–. Die Armee-worm [microform]: Cirphus (leucania) unipuncta Haw.. (Légionnaires Chenilles); Insectes nuisibles; Schädlinge; Armee - Worms. 23 Hulk der Kulturpflanzen. Als outbroak wurde hpcoming umfangreicher Ami ernster, eine Sondersitzung des County Council wurde im Rathaus in Brantford, um die Situation zu besprechen, und die meisten effir='nt Methoden der Kontrolle. Wandte ich mich an den Rat, zur Festlegung besonderer Nachdruck auf prompte und Co-opera-tion, während Herr Schuyler aus den schwerwiegenden Mangel an Hilfe mit der Invasion zu bewältigen. Nach einer kurzen Diskussion, geführt von Herrn Fischer, M.P.
 . Die Maisernte: Eine Diskussion von Mais, Sorghum, kafirs und wie in den USA und Kanada angebaut. Mais; Kafir Mais, Sorghum. Abb. 49. - Spezielle Anlagen für Mais Pflanzmaschine Schuhe. Im Mai gepflanzt war 73 Bushel pro Acre, während der durchschnittliche Ertrag der drei verbleibenden Anpflanzungen, einer im April und zwei im Juni, war 63 Bushel pro Acre. Viele Experimente an anderen Stationen tragen Sie die Aussage, dass es einen Zeitraum von etwa drei Wochen für Mais anpflanzen mit gleichen Chancen auf Erfolg, aber es gibt gelegentlich Jahreszeiten, wenn die sehr früh oder sehr spät Anlage- nungen sind am besten. Die optimale Jahreszeit Stockfotohttps://www.alamy.de/image-license-details/?v=1https://www.alamy.de/die-maisernte-eine-diskussion-von-mais-sorghum-kafirs-und-wie-in-den-usa-und-kanada-angebaut-mais-kafir-mais-sorghum-abb-49-spezielle-anlagen-fur-mais-pflanzmaschine-schuhe-im-mai-gepflanzt-war-73-bushel-pro-acre-wahrend-der-durchschnittliche-ertrag-der-drei-verbleibenden-anpflanzungen-einer-im-april-und-zwei-im-juni-war-63-bushel-pro-acre-viele-experimente-an-anderen-stationen-tragen-sie-die-aussage-dass-es-einen-zeitraum-von-etwa-drei-wochen-fur-mais-anpflanzen-mit-gleichen-chancen-auf-erfolg-aber-es-gibt-gelegentlich-jahreszeiten-wenn-die-sehr-fruh-oder-sehr-spat-anlage-nungen-sind-am-besten-die-optimale-jahreszeit-image232094182.html
. Die Maisernte: Eine Diskussion von Mais, Sorghum, kafirs und wie in den USA und Kanada angebaut. Mais; Kafir Mais, Sorghum. Abb. 49. - Spezielle Anlagen für Mais Pflanzmaschine Schuhe. Im Mai gepflanzt war 73 Bushel pro Acre, während der durchschnittliche Ertrag der drei verbleibenden Anpflanzungen, einer im April und zwei im Juni, war 63 Bushel pro Acre. Viele Experimente an anderen Stationen tragen Sie die Aussage, dass es einen Zeitraum von etwa drei Wochen für Mais anpflanzen mit gleichen Chancen auf Erfolg, aber es gibt gelegentlich Jahreszeiten, wenn die sehr früh oder sehr spät Anlage- nungen sind am besten. Die optimale Jahreszeit Stockfotohttps://www.alamy.de/image-license-details/?v=1https://www.alamy.de/die-maisernte-eine-diskussion-von-mais-sorghum-kafirs-und-wie-in-den-usa-und-kanada-angebaut-mais-kafir-mais-sorghum-abb-49-spezielle-anlagen-fur-mais-pflanzmaschine-schuhe-im-mai-gepflanzt-war-73-bushel-pro-acre-wahrend-der-durchschnittliche-ertrag-der-drei-verbleibenden-anpflanzungen-einer-im-april-und-zwei-im-juni-war-63-bushel-pro-acre-viele-experimente-an-anderen-stationen-tragen-sie-die-aussage-dass-es-einen-zeitraum-von-etwa-drei-wochen-fur-mais-anpflanzen-mit-gleichen-chancen-auf-erfolg-aber-es-gibt-gelegentlich-jahreszeiten-wenn-die-sehr-fruh-oder-sehr-spat-anlage-nungen-sind-am-besten-die-optimale-jahreszeit-image232094182.htmlRMRDGPDX–. Die Maisernte: Eine Diskussion von Mais, Sorghum, kafirs und wie in den USA und Kanada angebaut. Mais; Kafir Mais, Sorghum. Abb. 49. - Spezielle Anlagen für Mais Pflanzmaschine Schuhe. Im Mai gepflanzt war 73 Bushel pro Acre, während der durchschnittliche Ertrag der drei verbleibenden Anpflanzungen, einer im April und zwei im Juni, war 63 Bushel pro Acre. Viele Experimente an anderen Stationen tragen Sie die Aussage, dass es einen Zeitraum von etwa drei Wochen für Mais anpflanzen mit gleichen Chancen auf Erfolg, aber es gibt gelegentlich Jahreszeiten, wenn die sehr früh oder sehr spät Anlage- nungen sind am besten. Die optimale Jahreszeit
 . Muscheln als Beweis für die Migration der frühen Kultur von J. Wilfrid Jackson... Schalen; Purpura; Musikinstrumente, Primitive; Perlen; Kaurischnecken. Oi'iila (Calpiiiniis) verrucosa L.A. - Philippinen (nach keeve). B.-alten amerikanischen Gräber (nach Holmes). Herr W. li. Holmes, in seiner "Kunst in der Schale der alten Amerikaner, "^"* zeigt in der Platte xxxii. Eine Reihe von gelochten marine Muscheln aus alten Gräbern von Nordamerika, zwei Dieser (Abbn exhumiert. 11 und 12) sind von besonderem Interesse, die in den Geltungsbereich der gegenwärtigen Diskussion. Leider ist die genaue Daten über Stockfotohttps://www.alamy.de/image-license-details/?v=1https://www.alamy.de/muscheln-als-beweis-fur-die-migration-der-fruhen-kultur-von-j-wilfrid-jackson-schalen-purpura-musikinstrumente-primitive-perlen-kaurischnecken-oiiila-calpiiiniis-verrucosa-la-philippinen-nach-keeve-b-alten-amerikanischen-graber-nach-holmes-herr-w-li-holmes-in-seiner-kunst-in-der-schale-der-alten-amerikaner-zeigt-in-der-platte-xxxii-eine-reihe-von-gelochten-marine-muscheln-aus-alten-grabern-von-nordamerika-zwei-dieser-abbn-exhumiert-11-und-12-sind-von-besonderem-interesse-die-in-den-geltungsbereich-der-gegenwartigen-diskussion-leider-ist-die-genaue-daten-uber-image232126150.html
. Muscheln als Beweis für die Migration der frühen Kultur von J. Wilfrid Jackson... Schalen; Purpura; Musikinstrumente, Primitive; Perlen; Kaurischnecken. Oi'iila (Calpiiiniis) verrucosa L.A. - Philippinen (nach keeve). B.-alten amerikanischen Gräber (nach Holmes). Herr W. li. Holmes, in seiner "Kunst in der Schale der alten Amerikaner, "^"* zeigt in der Platte xxxii. Eine Reihe von gelochten marine Muscheln aus alten Gräbern von Nordamerika, zwei Dieser (Abbn exhumiert. 11 und 12) sind von besonderem Interesse, die in den Geltungsbereich der gegenwärtigen Diskussion. Leider ist die genaue Daten über Stockfotohttps://www.alamy.de/image-license-details/?v=1https://www.alamy.de/muscheln-als-beweis-fur-die-migration-der-fruhen-kultur-von-j-wilfrid-jackson-schalen-purpura-musikinstrumente-primitive-perlen-kaurischnecken-oiiila-calpiiiniis-verrucosa-la-philippinen-nach-keeve-b-alten-amerikanischen-graber-nach-holmes-herr-w-li-holmes-in-seiner-kunst-in-der-schale-der-alten-amerikaner-zeigt-in-der-platte-xxxii-eine-reihe-von-gelochten-marine-muscheln-aus-alten-grabern-von-nordamerika-zwei-dieser-abbn-exhumiert-11-und-12-sind-von-besonderem-interesse-die-in-den-geltungsbereich-der-gegenwartigen-diskussion-leider-ist-die-genaue-daten-uber-image232126150.htmlRMRDJ77J–. Muscheln als Beweis für die Migration der frühen Kultur von J. Wilfrid Jackson... Schalen; Purpura; Musikinstrumente, Primitive; Perlen; Kaurischnecken. Oi'iila (Calpiiiniis) verrucosa L.A. - Philippinen (nach keeve). B.-alten amerikanischen Gräber (nach Holmes). Herr W. li. Holmes, in seiner "Kunst in der Schale der alten Amerikaner, "^"* zeigt in der Platte xxxii. Eine Reihe von gelochten marine Muscheln aus alten Gräbern von Nordamerika, zwei Dieser (Abbn exhumiert. 11 und 12) sind von besonderem Interesse, die in den Geltungsbereich der gegenwärtigen Diskussion. Leider ist die genaue Daten über